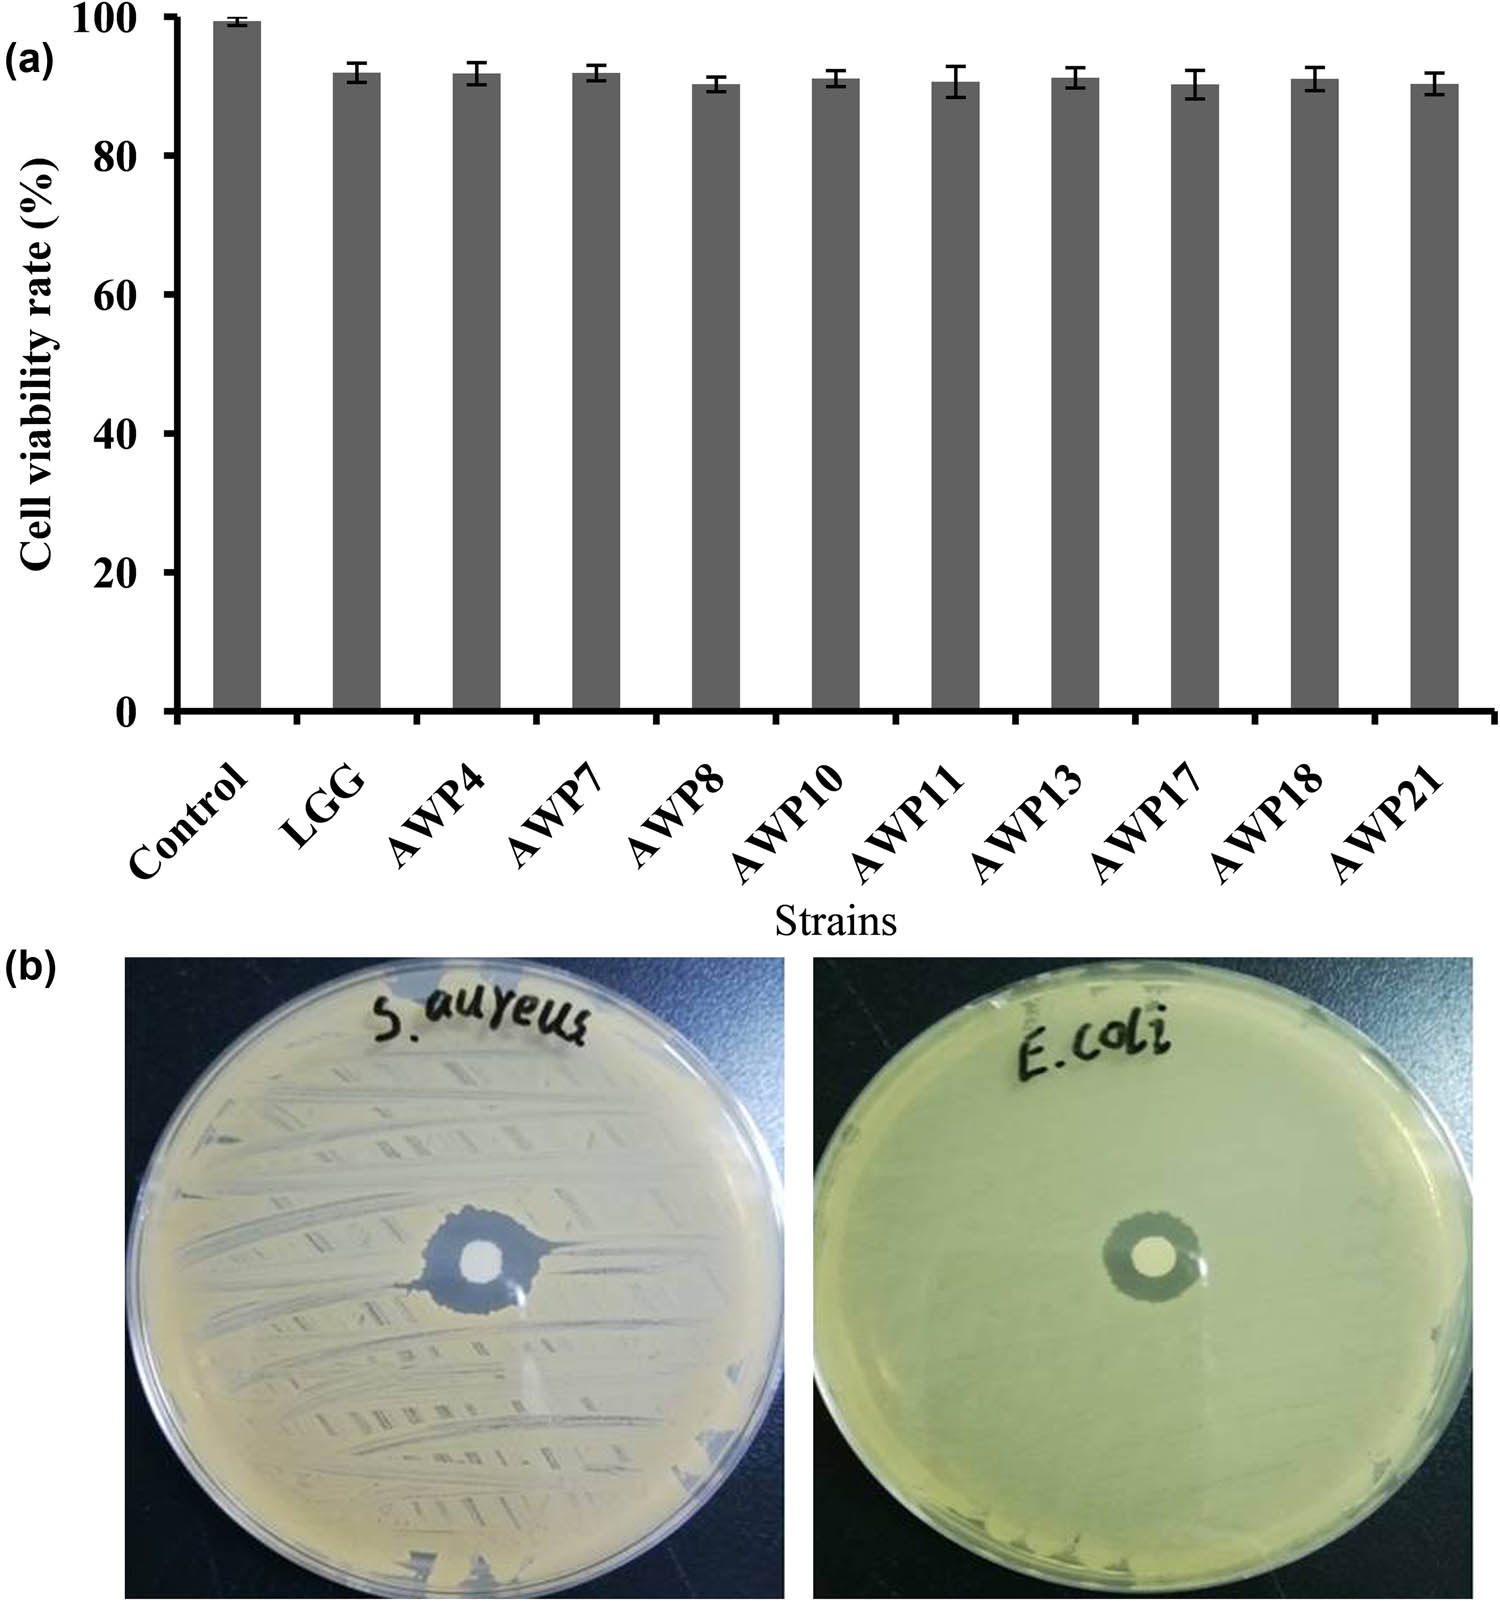

In vitro evaluation of lactic acid bacteria with probiotic activity isolated from local pickled leaf mustard from Wuwei in Anhui as substitutes for chemical synthetic additives
Abstract
The extensive abuse of chemical synthetic additives has raised increased attention to food safety. As substitutes, probiotics play an important role in human health as they balance the intestinal microbes in host. This study was aimed to isolate and evaluate the potential probiotic activities of lactic acid bacteria (LAB) from a local pickled leaf mustard (PLM) from Wuwei city in Anhui province through in vitro experiments. A total of 17 LAB strains were obtained as probiotics. All the isolates were sensitive to chloramphenicol, tetracycline, erythromycin, and doxycycline but exhibited resistance to antibiotics (e.g., streptomycin, kanamycin, gentamicin, and vancomycin). Out of the 17 strains, 9 were sensitive to most of the antibiotics and had no cytotoxic activity on human colorectal adenocarcinoma cell line (HT-29) cells. The isolated AWP4 exhibited antibacterial activity against four indicator pathogen strains (ATCC8099: Escherichia coli, ATCC6538: Staphylococcus aureus, ATCC9120: Salmonella enteric, and BNCC192105: Shigella sonnei). Based on the phylogenetic analysis of the 16S rRNA gene, AWP4 belonged to Lactiplantibacillus plantarum. This study indicated that the Wuwei local PLM could be a potential resource to isolate beneficial LAB as probiotics. The data provide theoretical guidance for further animal experiments to estimate the probiotic effect and safety of Lpb. plantarum AWP4 in vivo.
1 Introduction
The growing concern of consumers for food safety due to the extensive abuse of chemical synthetic additives has prompted the search for green and secure food additives to replace the chemical synthetic ones [1]. Increased attention has been paid to the development of probiotic foods because they could prevent diseases. Probiotics are different kinds of living bacteria that have beneficial health effects on humans [2,3]. At present, probiotics are not only used as antibiotic substitutes to prevent or heal several diseases [4] but also applied as additives in food products to inhibit the growth of pathogenic microorganisms [5,6]. Most bacteria considered as probiotics belong to lactic acid bacteria (LAB), such as Bifidobacterium and Lactiplantibacillus [7]. LAB could produce many kinds of active metabolites, and they are widely used in healthcare, food fermentation, and industrial additives [8,9,10,11]. Dairy products are the most convenient and suitable carriers for probiotics to provide consumers with health benefits [12]. However, high sugar and cholesterol and lactose intolerance in dairy products are the major bottlenecks that restrict the development of dairy-derived probiotic products. Screening of probiotic LAB strains from plant-derived foods is a potential method to overcome these drawbacks [13]. Therefore, new probiotics are worth isolating from the relatively undeveloped niche.
Pickled leaf mustard (PLM) is a classic representative of traditional fermented vegetable food in South China, and it has a huge number of consumers because of its unique flavor, crisp taste, rich nutrition, and healthcare functions. Pickles are a natural storehouse of LAB, such as Lactiplantibacillus spp., Leuconostoc spp., and Weissella spp., which are all potential probiotic microbes [14,15,16]. For instance, W. Ciabia JW15 strain isolated from kimchi exhibited probiotic, immune stimulation, and antioxidant activities [17]. However, studies on the isolation of LAB as potential probiotics from a local PLM in Wuwei city of Anhui province have not been reported yet.
Probiotics are specific bacterial strains that promote health functions. However, the bacterial strains used as probiotics must be tested for their safety before formal application, and their probiotic functions should be evaluated subsequently. Safety assays include fast and precise identification, antibiotic sensitivity, and nonpathogenicity [18,19]. Detection of functions includes intestinal adhesion and resistance to gastrointestinal environment [20]. Moreover, prebiotic evaluation includes antibacterial activity, cholesterol assimilation, and inhibition of α-amylase activity [21]. The resistance of gastrointestinal environment and intestinal adhesion capacity are considered the most critical prerequisites for probiotic LAB [22]. Oxidative stress is one of the main risk factors for diseases. Excessive production of reactive oxygen species could cause chronic diseases, such as nervous system or cardiovascular diseases and rheumatoid arthritis [23]. Therefore, the potential probiotic activities of LAB are important indicators of their application in food products.
Taken together, further work should be performed to obtain and identify new LAB for their application in food products. Therefore, this study was aimed to isolate and evaluate the potential probiotic activities of LAB strains derived from Wuwei city’s local PLM in Anhui province. Moreover, further tests, including antibacterial activity, adhesion and antioxidant capacities, cholesterol assimilation, and α-amylase inhibition, were carried out. This study provided new information on how to obtain more beneficial LAB strains, which could be further used in the food industry as additives.
2 Materials and methods
2.1 Isolation of LAB and growth condition
PLM was selected from Wucheng town, Wuwei city (E 117°28′, N 30°56′), Anhui province, China. The samples were mixed under sterile condition and diluted to 10−8–10−9. One hundred microliters of solution (10−9) were plated on De-man, Rogosa, and Sharpe (MRS) agar medium (Qingdao Hope Bio-technology Co., Ltd.; containing 1% CaCO3) and incubated at 37°C for 48 h in anaerobic environment. The criteria used were according to the reported methods [22,23]. The morphological characteristics of the colonies and Gram staining were observed, and catalases and biochemical reactions were evaluated using a commercial kit (Qingdao Hope Bio-Technology Co., Ltd). Single white colonies that were Gram-positive and had calcium dissolving circle were selected and purified by streaking on MRS agar more than three times. The purified strains were preserved in MRS broth with 20% (v/v) glycerol and kept at −80°C. The strains were activated in MRS broth at 37°C for 48 h before use. One model strain Lactiplantibacillus rhamnosus GG ATCC53103 (LGG) was used as the control.
2.2 Sequencing of 16S rRNA gene
The genomic DNA of AWP4 was extracted using a bacterial DNA kit (Tiangen Biotech Co., Ltd.) in accordance with the manufacturer’s instructions. Primers 27f (5′-AGAGTTGATCCTGGCTCAG-3′) and 1492r (5′-GGTATCCTTGTTACTACTT-3′) were used [24]. Fifty microliters of mixed solution (1.0 μL Taq DNA polymer, 5.0 μL 10× PCR buffer containing 2.5 mM Mg2+, 1.0 μL 10 mM dNTPs, and 39.0 μL ddH2O, 1.0 μL DNA template, and 1.5 μL primer) was used. The PCR parameters were set as follows: initial denaturation at 95°C for 5 min, followed by 35 cycles at 95°C for 30 s, at 58°C for 30 s, and at 72°C for 90 s, and a final elongation at 72°C for 7 min. The PCR amplification fragments were visualized using 1% agarose. The PCR products were sequenced by Shanghai Personal Gene Technology Co., Ltd. The 16S rRNA gene sequence was compared and matched with the sequences in NCBI GenBank. The sequenced genes were analyzed, and a phylogenetic tree was constructed using MEGA 6.0 with 1,000 bootstrap replications.
2.3 Hemolysis test, antibiotic susceptibility, and cytotoxic activity assays
Hemolysis test was performed as previously described [25]. The LAB strains were incubated on blood agar plate with 5% (v/v) sterilized defibrinated sheep blood for 48 h at 37°C. The strains displaying β-hemolysis were considered as having no probiotic property [26]. All LAB strains that displayed negative results were subjected to subsequent assays. Antibiotic susceptibility was assessed using disc agar diffusion method [27] with minor modifications. Approximately 100 μL of cells of LAB (107 CFU mL−1) were plated on MRS agar plate. The discs containing antibiotics were placed on the surface of the medium, and the plates were incubated at 37°C for 24–48 h. The concentrations of antibiotics were set as follows: 5 μg mL−1 for metronidazole, rifampicin, and ciprofloxacin; 10 μg mL−1 for streptomycin, ampicillin, and gentamicin; 15 μg mL−1 for erythromycin; and 30 μg mL−1 for chloramphenicol, tetracycline, doxycycline, kanamycin, and vancomycin. The inhibition diameter of the circle was measured using the method reported by Clinical and Laboratory Standards Institute [28]. The cytotoxic activity of LAB strains on HT-29 was evaluated using 3-(4,5-dimethylthiazol-2-yl)-2,5-diphenyltetrazolium bromide (MTT) assay [29] with few modifications. In brief, the HT-29 cells were transferred into a 24-well plate (1 × 104 cells per well) in Dulbecco’s modified Eagle: F12 medium (DMEM/F12; Gibco, USA) with 10% fetal bovine serum and maintained under a humidified atmosphere of 5% CO2 at 37°C for 24 h. Subsequently, the cells were washed with phosphate buffer saline (PBS) solution three times and then treated with 200 mL of MTT solution (0.5 mg mL−1) for 3.5 h. Cell viability was measured using the following formula:
2.4 Evaluation of probiotic properties
2.4.1 Resistance to artificially simulated gastrointestinal juices
The resistance to simulated gastrointestinal juices was evaluated with few modifications [30,31]. In brief, the LAB strains were incubated in MRS broth supplemented with 0.1% (w/v) ascorbic acid at 37°C for 48 h. The pellets were washed twice with PBS (pH 7.4). A total of 4 mL of artificially simulated gastric juice (125 mM NaCl, 7 mM KCl, 45 mM NaHCO3, and 3 g L−1 pepsin; pH 2.0; Shanghai Lanji Technology Development Co., Ltd.) were used. The bacterial cells (108 CFU mL−1) were kept in a water bath at 37°C for 3 h. The cells were obtained by centrifugation at 10,000×g for 10 min, and the pellets were washed twice with PBS. Four milliliters of artificially simulated intestinal juice (22 mM NaCl, 3.2 mM KCl, 7.6 mM NaHCO3, 1 g L−1 pancreatin [Shanghai Lanji Technology Development Co., Ltd.], and 3 g L−1 bovine bile salts [pH 8.0; Beijing Solarbio Science and Technology Co., Ltd]) were used to suspend the cells in a water bath at 37°C for 5 h. A concentration (10−9) of cells was plated on the MRS agar medium. The number of viable bacteria was observed by colony counting.
2.4.2 Antibacterial activity assay
Fresh LAB bacterial strains were inoculated in MRS broth at 2% inoculation amount at 37°C for 48 h. The fermentation liquid was collected with centrifugation at 4°C and 8,000 rpm for 10 min, filtrated using a 0.22 μm filter membrane, and stored at 4°C for further use. The inhibitory effects of the LAB strains on the indicator pathogens were investigated using the disc diffusion method [24] with few modifications. Four pathogenic strains (ATCC8099: Escherichia coli, ATCC6538: Staphylococcus aureus, ATCC9120: Salmonella enteric, and BNCC192105: Shigella sonnei) were used as indicators and preserved by the Institute of Microbiology, Anhui Academy of Medical Sciences, China. Approximately 100 μL of indicator pathogenic strains (107 CFU mL−1) was plated on Luria–Bertani agar plates. The inhibition circle was measured to assess the antibacterial activity of the LAB strains.
2.4.3 Inhibition of intestinal adherence on pathogenic bacteria
The inhibition of intestinal adherence on pathogenic bacteria was estimated as previously described [22] with slight modifications. The HT-29 cells (Hunan Fenghui Biotechnology Co., Ltd.) were added to the sterilized cell culture bottle and maintained in DMEM/F12 supplemented with 10% (v/v) fetal bovine serum (Zhengjiang Tianhang Biotechnology Co., Ltd.) under a humidified atmosphere of 5% CO2 at 37°C. The HT-29 cells were harvested after being incubated to 80–90% confluences. Subsequently, the cells were added into the 24-well plate (2 × 106 cells per well) and maintained in DMEM/F12 with 10% fetal bovine serum for 48 h under the condition of 5% CO2 at 37°C. The medium was refreshed every day. Equal volumes of LAB (1 × 108 CFU mL−1) and pathogenic bacteria (1 × 108 CFU mL−1) were added into the wells and incubated at 37°C for 2 h. The following formula was used:
2.5 Adhesion capacity test
2.5.1 Determination of cell-surface hydrophobicity
Cell-surface hydrophobicity was determined using the protocol described by Mohanty et al. [32] with minor modifications. The culture of the LAB was centrifuged at 10,000 rpm for 10 min, the supernatant was removed, and the cell precipitate was washed twice with phosphate urea magnesium buffer. The LAB suspension was adjusted to 0.7 at 600 nm. One-third volume of n-hexadecane was added into the LAB suspension and incubated for 1 h at 37°C. The aqueous phase was carefully separated to measure its absorbance value (600 nm). The hydrophobicity was calculated as follows:
2.5.2 Auto-aggregation and co-aggregation assays
Auto-aggregation was evaluated with few modifications [33]. The LAB strains were cultivated overnight at 37°C on anaerobic conditions and then the cells were centrifuged at 12,000×g for 10 min at 4°C. The cell pellets were washed three times with PBS and suspended to a concentration of 108 CFU mL−1. The incubation condition was 37°C for 4 h. The absorbance value at 600 nm was determined as follows:
2.5.3 Mucin binding test
The procedure used for mucin binding assay was as described previously [35]. One hundred microliters of 10 mg mL−1 pig mucin solution prepared using PBS (pH = 7.2) were added to the microtitration holes in the 96-well plate (Corning, USA) and incubated overnight at 4°C. The holes were washed twice with PBS and saturated for 4 h at 4°C with 200 mL of 2% (w/v) bovine serum protein (Beijing Solarbio Science and Technology Co., Ltd). The cell cultures were set to a final concentration of 1 × 108 CFU mL−1. The aliquots of the 100 mL suspension above was added into each well and incubated for 1 h at 37°C. The holes were washed 12 times with 1 mL of PBS solution and then 200 mL of 0.5% (v/v) Triton X-100 solution was added into the holes and incubated at 25°C for 2 h with regular vibration to release the adhered bacteria. The suspension of appropriate concentration was coated on MRS plates and incubated at 37°C for 24 h under anaerobic conditions. PBS was used as the negative control. The mucin binding rate was calculated using the following formula:
2.6 2,2-Diphenyl-1-picrylhydrazyl (DPPH) radical scavenging activity and (2,2-azinodi-3-ethylbenzthiazoline sulfonate) ABTS+ radical and hydroxyl scavenging activities
The DPPH radical scavenging activity was assessed in accordance with the reported method [17] with few modifications. A volume of 0.2 mL of LAB cell suspension (1 × 109 CFU mL−1) or PBS solution was added into 1 mL of DPPH solution in methanol (100 mM), vortexed for 30 s, and incubated in the dark at 37°C for 20 min, followed by centrifugation at 8,000×g for 5 min. The absorbance value at 517 nm was determined. The PBS solution was used as the blank control. The DPPH radical scavenging activity was calculated as follows:
2.7 Cholesterol assimilation assay and α-amylase inhibition activity
Cholesterol assimilation was determined using the previous method [37] with few modifications. In brief, the LAB strains were inoculated in MRS broth medium at 2%, with an OD600 nm of 0.5. Then 150 μg mL−1 of water-soluble cholesterol (Beijing Solarbio Science and Technology Co., Ltd.) and 0.3% bile (w/v) were added into the culture and cultivated overnight at 37°C. Then the residual cholesterol in the cultivation solution was determined. The absorbance value was determined at 540 nm. The PBS solution was used as the control. The cholesterol assimilation rate was calculated as follows:
2.8 Statistical analysis
Experiments were carried in triplicate, and all data were calculated as mean values and standard deviations. Data analysis was performed on SPSS version 23.0 (IBM, USA). The difference was estimated by one-way ANOVA with Duncan’s multiple range test, and statistical significances were calculated at P < 0.05 level.
-
Ethical approval: The conducted research is not related to either human or animal use.
3 Results
3.1 Physiological and biochemical characteristics of isolates
A total of 24 isolates were obtained after the preliminary physiological and biochemical experiments. A schematic of the LAB screening processes is shown in Figure 1. The morphological and phenotypic characteristics of the isolated colonies showed the characteristics of smooth surface, round, and porcelain white. The results revealed that all the 24 isolates were Gram-positive, long rod-shaped, or rod-shaped. Combined with the physiological and biochemical identification of standard Lactiplantibacillus, 17 out of 24 isolates were putatively identified as LAB (Table 1).

Schematic of LAB screening processes.
Physiological and biochemical identification results of 17 LAB strains
| Tested item | Strain numbersa | Strain AWP4 |
|---|---|---|
| Glucose gas production | − | − |
| Gelatin | 5 | − |
| Catalase | − | − |
| 6.5% Nacl | 8 | − |
| 18% Nacl | 3 | − |
| 15°C growth test | + | + |
| 45°C growth test | + | + |
| Arabinose | + | + |
| Cellobiose | 11 | + |
| Esculin | 13 | + |
| Fructose | 10 | + |
| Gluconate | 13 | + |
| Lactose | 9 | + |
| Mannose | 8 | + |
| Mannitol | 11 | + |
| Sorbitol | 10 | + |
| Melezitose | + | + |
| Melibiose | 9 | + |
| Raffinose | 7 | + |
| Rhamnose | 5 | − |
| Salicin | 7 | + |
| Glucose | 14 | + |
| Sucrose | 10 | + |
| Trehalose | 9 | + |
| Xylose | − | − |
| Inulin | 6 | + |
| Maltose | 11 | + |
16 isolates were listed (AWP1, AWP3, AWP5, AWP6, AWP7, AWP8, AWP9, AWP10, AWP11, AWP13, AWP16, AWP17, AWP18, AWP20, AWP21, and AWP22).
+: positive or weakly positive reaction, −: negative reaction.
Number: the number of positive reaction.
- a
Number of positive strain in this item.
3.2 Safety evaluation of LAB strains
The results of 17 LAB strains showed negative hemolysis test, indicating that all the strains had no hemolysis and were safe for further use. All the 17 isolates were sensitive to chloramphenicol, tetracycline, erythromycin, and doxycycline and resistant to metronidazole, streptomycin, kanamycin, gentamicin, vancomycin, and ciprofloxacin. Among them, 12 were sensitive to ampicillin, while the remaining 5 strains were resistant to it. Eleven strains were sensitive to rifampicin, and the remaining six were resistant to it (Table 2). Out of the 17 isolates, 9 (including AWP4, AWP7, AWP8, AWP10, AWP11, AWP13, AWP17, AWP18, and AWP21) were sensitive to most antibiotics, and they were selected for further analysis.
Antibiotic susceptibility results of isolated LAB strains
| Strains | Antibiotics | |||||||||||
|---|---|---|---|---|---|---|---|---|---|---|---|---|
| Metronidazole | Chloramphenicol | Streptomycin | Kanamycin | Ampicillin | Gentamicin | Tetracycline | Erythromycin | Rifampicin | Ciprofloxacin | Doxycycline | Vancomycin | |
|
|
|
|
|
|
|
|
|
|
|
|
|
| AWP1 | R | S | R | R | S | R | S | S | R | R | S | R |
| AWP3 | R | S | R | R | R | R | S | S | S | R | S | R |
| AWP4 | R | S | R | R | S | R | S | I | S | R | S | R |
| AWP5 | R | S | R | R | S | R | S | S | R | R | S | R |
| AWP6 | R | S | R | R | S | R | S | S | R | R | S | R |
| AWP7 | R | S | R | R | S | R | S | S | S | R | S | R |
| AWP8 | R | S | R | R | S | R | S | S | S | R | S | R |
| AWP9 | R | S | R | R | R | R | S | S | R | R | S | R |
| AWP10 | R | S | R | R | S | R | I | S | S | R | S | R |
| AWP11 | R | I | R | R | S | R | S | S | S | R | S | R |
| AWP13 | R | S | R | R | S | R | S | I | S | R | S | R |
| AWP16 | R | S | R | R | R | R | S | S | R | R | S | R |
| AWP17 | R | S | R | R | S | R | S | S | S | R | S | R |
| AWP18 | R | S | R | R | S | R | S | S | S | R | S | R |
| AWP20 | R | S | R | R | R | R | S | I | R | R | S | R |
| AWP21 | R | S | R | R | S | R | S | S | S | R | S | R |
| AWP22 | R | I | R | R | R | R | S | I | S | R | S | R |
| LGG | R | S | R | R | R | R | R | R | S | R | S | R |
R: resistant to antibiotics, I: intermediately sensitive to antibiotics, S: sensitive to antibiotics.
LGG: Lactiplantibacillus rhamnosus GG ATCC53103.
MTT method was used to determine the cytotoxic activities of the nine isolated LAB strains on HT-29 cell line (Figure 2a). The cell viability rates of the nine isolates were still at a high level, ranging from 90.26% to 91.92%, and their cytotoxic activities on HT-29 cells were all less than 10%. Compared with the control strain (Lactiplantibacillus rhamnosus GG ATCC53103, LGG), the nine LAB strains had no cytotoxic activities on HT-29 cells.
Cell viability of isolated LAB strains (a) and inhibition of indicator strains (b). Error bars represent deviations of mean values (n = 3).
3.3 Resistance to artificially simulated gastrointestinal juices
Out of the 17 LAB strains, 9 were selected to test their resistance to artificially simulated gastrointestinal juices (Table 3). Most of the selected strains exhibited a strong resistance. Among them, seven retained high viability, but the viable counts of AWP8 and AWP18 declined sharply. After treatment with artificially simulated intestinal juice was subsequently conducted for 5 h, six strains displayed high cell survival level, whereas three (AWP8, AWP13, and AWP18) showed a low survival level. The referenced strain LGG showed low tolerance to artificially simulated gastrointestinal juices. Given their high resistance to gastrointestinal juices, AWP4, AWP7, AWP10, AWP11, AWP17, and AWP21 were chosen for testing their antibacterial activities.
Survival of LAB cells simulated by artificial gastrointestinal juices (log 10 CFU mL−1)
| Strains | Artificially simulated gastric juice | Artificially simulated intestinal juice |
|---|---|---|
| AWP4 | 7.88 ± 0.30d | 7.87 ± 0.27c |
| AWP7 | 8.04 ± 0.22d | 8.01 ± 0.17c |
| AWP8 | <4 ± 0.00a | <4 ± 0.00a |
| AWP10 | 7.92 ± 0.17d | 7.90 ± 0.22c |
| AWP11 | 8.10 ± 0.14d | 8.03 ± 0.13c |
| AWP13 | 7.04 ± 0.24c | <4 ± 0.00a |
| AWP17 | 7.87 ± 0.25d | 7.85 ± 0.28c |
| AWP18 | <4 ± 0.00a | <4 ± 0.00a |
| AWP21 | 7.94 ± 0.17d | 7.91 ± 0.14c |
| LGG | 6.12 ± 0.15b | 4.85 ± 0.21b |
Data are presented as mean ± SD in triplicate. a–d: different superscript lowercase letters in the same column indicate significant difference (P < 0.05).
3.4 Antibacterial activity of LAB strains
Disc diffusion method was performed to determine the antibacterial activities of the six strains against E. coli, S. aureus, S. enterica, and S. sonnei (Table 4). Among them, three exhibited a certain inhibition on the growth of four indicator pathogens, which had a broad spectrum of bacteriostasis. The proliferation of E. coli and S. enterica could be inhibited by all the six LAB strains. Among them, two strains (AWP4 and AWP17) had the strongest antibacterial effect on E. coli, with over 18 mm of inhibition zone in diameter (Figure 2b). AWP4 also displayed the strongest bacteriostatic effect on the growth of S. enterica. However, AWP10 and AWP21 showed the weakest antibacterial effect on E. coli and S. enterica. The growth of S. aureus and S. sonnei was inhibited by five and three LAB strains, respectively. The growth of S. aureus could not be inhibited by AWP21, while the inhibition effect of AWP10, AWP17, and AWP21 on S. sonnei was not detected. LGG exhibited excellent antibacterial activities on the four selected indicator pathogens. Three strains, namely, AWP4, AWP7, and AWP11, which all had antibacterial activities on the four selected indicator pathogens, were selected for the analysis of the inhibition effect on the intestinal adherence of pathogenic bacteria.
Antimicrobial activity of LAB strains isolated from Anhui Wuwei local PLM
| Strains | Diameter of inhibit zone (mm) | |||
|---|---|---|---|---|
| E. coli | S. aureus | S. enterica | S. sonnei | |
| AWP4 | 19.31 ± 1.09c | 14.92 ± 1.24b | 19.44 ± 1.22c | 11.50 ± 0.85a |
| AWP7 | 16.23 ± 1.25b | 13.35 ± 0.62ab | 14.69 ± 0.81b | 18.27 ± 1.52c |
| AWP10 | 9.18 ± 0.88a | 12.13 ± 0.98a | 9.54 ± 0.79a | — |
| AWP11 | 15.70 ± 0.90b | 22.12 ± 1.82d | 15.57 ± 1.04b | 19.78 ± 1.58c |
| AWP17 | 18.29 ± 1.17c | 12.66 ± 1.29ab | 14.46 ± 1.27b | — |
| AWP21 | 10.58 ± 0.94a | — | 9.16 ± 0.37a | — |
| LGG | 21.34 ± 1.23d | 17.37 ± 0.87c | 19.92 ± 1.41c | 15.59 ± 0.85b |
Data are presented as mean ± SD in triplicate. a–d: different superscript lowercase letters in the same column indicate significant difference (P < 0.05); —: no inhibition zone.
3.5 Inhibition effect on intestinal adherence of pathogenic bacteria
The three LAB strains showed excellent inhibition abilities on intestinal adherence of the four indicator pathogens. The inhibition rate ranged from 46.92 to 63.67% (Table 5). Among them, AWP4 exhibited the highest inhibition rate of 63.67% on E. coli, significantly higher than LGG (49.49%). AWP7 showed the lowest inhibition effect on E. coli, with an inhibition rate of 51.05%, also higher than LGG. However, the difference was not significant. AWP11 possessed the highest inhibition rate of 60.84% on S. enterica, while AWP7 had the lowest at 58.32%. However, no significant difference in the inhibition effect on S. enterica was observed among the three LAB strains. The intestinal adherence of S. aureus and S. sonnei was inhibited by AWP11, with the highest inhibition rates of 56.95 and 53.53%, respectively. These rates were significantly higher than those of LGG. Given that AWP4, AWP7, and AWP11 exhibited greater inhibition effect on the intestinal adherence of pathogenic bacteria, they were selected to evaluate their adhesion activities.
Inhibition effect of intestinal adherence on pathogenic bacteria of LAB strains
| Strains | Inhibition ratio of intestinal adherence (%) | |||
|---|---|---|---|---|
| E. coli | S. aureus | S. enterica | S. sonnei | |
| AWP4 | 63.67 ± 6.31b | 47.98 ± 5.73ab | 59.87 ± 6.23a | 46.92 ± 4.88ab |
| AWP7 | 51.05 ± 4.36a | 47.26 ± 4.11ab | 58.32 ± 5.50a | 48.60 ± 5.40ab |
| AWP11 | 57.72 ± 7.76ab | 56.95 ± 5.82b | 60.84 ± 2.35a | 53.53 ± 4.33b |
| LGG | 49.49 ± 4.93a | 44.60 ± 4.67a | 58.17 ± 5.22a | 42.48 ± 3.47a |
Data are presented as the mean ± SD in triplicate. a and b: different letters in the same column indicate significant difference (P < 0.05).
3.6 Adhesion capacities of LAB strains
The cell-surface hydrophobicity to n-hexadecane and auto-aggregation; the co-aggregation with four pathogens, including E. coli, S. aureus, S. enterica, and S. sonnei; and the mucin binding of the three LAB strains were evaluated (Tables 6 and 7). All the three selected LAB strains exhibited a certain cell-surface hydrophobicity. The ratio of cell-surface hydrophobicity ranged from 40.80% to 54.27%. AWP7 displayed the highest hydrophobicity ratio among the three strains, but compared with the control strain LGG (51.35%), no significant difference in the hydrophobicity ratio was observed. AWP11 showed the lowest hydrophobicity ratio. As shown in Table 6, the auto-aggregation ratios exhibited by the three strains ranged from high to low arrangement as follows: 48.78% (AWP7), 44.56% (AWP4), and 30.39% (AWP11). Out of the three LAB strains, AWP7 showed significantly higher auto-aggregation ratio than LGG (34.53%). The co-aggregation of the three LAB strains with the four pathogens was also estimated (Table 7). The co-aggregation ratio of AWP11 with E. coli was the highest at 33.13%, while that of AWP4 with S. sonnei was the lowest at 1.56%. The mucin binding characteristics of the three LAB strains were determined in the last part of adhesion capabilities measurement. The results are shown in Table 6. All the three LAB strains were able to bind to mucin within the range of 49.70–63.81%. Their mucin binding ratio was lower than that of LGG (65.16%). AWP7 possessed the highest binding ratio, though not significantly different from that of LGG.
Adhesion capacities of LAB strains
| Strains | Adhesion capacities (%) | ||
|---|---|---|---|
| Cell surface hydrophobicity | Auto-aggregation | Mucin binding | |
| AWP4 | 43.84 ± 3.35a | 44.56 ± 2.64b | 49.70 ± 3.98a |
| AWP7 | 54.27 ± 2.99b | 48.78 ± 4.06b | 63.81 ± 5.95b |
| AWP11 | 40.80 ± 3.08a | 30.39 ± 5.08a | 53.16 ± 4.40a |
| LGG | 51.35 ± 3.54b | 34.53 ± 3.87a | 65.16 ± 5.18b |
Data are presented as mean ± SD in triplicate. a and b: different superscript lowercase letters in the same column indicate significant difference (P < 0.05).
Co-aggregation property of LAB strains
| Strains | Co-aggregation (%) | |||
|---|---|---|---|---|
| E. coli | S. aureus | S. enterica | S. sonnei | |
| AWP4 | 16.46 ± 3.34a | 9.36 ± 3.07a | 26.95 ± 5.38bc | 1.56 ± 0.58a |
| AWP7 | 18.51 ± 2.56a | 23.84 ± 2.85b | 17.27 ± 2.64a | 5.91 ± 1.66b |
| AWP11 | 33.13 ± 2.53b | 31.66 ± 5.71c | 23.20 ± 3.69ab | 9.77 ± 0.75c |
| LGG | 31.95 ± 3.20b | 13.88 ± 2.97a | 31.85 ± 3.11c | 18.03 ± 3.10d |
Data are presented as mean ± SD in triplicate. a–d: different superscript lowercase letters in the same column indicate significant difference (P < 0.05).
3.7 In vitro antioxidant activity of LAB strains
The antioxidant activities of the three LAB strains were measured, including DPPH radial scavenging activity, ABTS+ radial scavenging activity, and hydroxyl radial scavenging activity (Figure 3). The DPPH radial scavenging activities were in the range of 233.15–936.82 μmol L−1. AWP4 exhibited significantly higher DPPH radial scavenging activity than the others, but it was lower than that of the reference strain LGG. AWP4, AWP7, and AWP11 showed ABTS+ radial scavenging activities of 666.92, 252.03, and 327.24 μmol L−1, respectively. The ABTS+ radial scavenging activity of AWP4 was significantly higher than that of AWP7 and AWP11. AWP4 displayed the highest hydroxyl radial scavenging activity of 1909.90 μmol L−1, while AWP7 showed the lowest hydroxyl radial scavenging activity of 140.97 μmol L−1. AWP4 exhibited significantly better antioxidant activities, including DPPH radial scavenging activity, ABTS+ radial scavenging activity, and hydroxyl radial scavenging activity, than the two other strains. Given its excellent antioxidant activity, AWP4 was further selected for 16S rRNA gene identification.

Antioxidant activity of LAB strains. Error bars represent deviations of mean values (n = 3). Values followed by different superscript letters indicate significant difference (P < 0.05).
3.8 Sequencing of 16S rRNA gene, cholesterol assimilation ability, and α-amylase activity
The inhibition ratio on the α-amylase activity of AWP4 was 34.05% (Figure 4a), which was significantly higher than that of LGG (24.78%). The cholesterol assimilation ability of AWP4 was also determined. The cholesterol assimilation rates of AWP4 and LGG were 49.72 and 52.74% (Figure 4b), respectively. The cholesterol assimilation rate of LGG was slightly higher than that of AWP4, but no significant difference was observed. AWP4 was identified as Lpb. plantarum (Figure 5). The 16S rRNA gene sequence of AWP4 was deposited to NCBI (accession number: MN 759440).

α-Amylase activity inhibition (a) and cholesterol assimilation ability (b) of AWP4. Error bars represent deviations of mean values (n = 3). *Significant difference (P < 0.05).

Phylogenetic tree constructed based on 16S rRNA gene sequence of AWP4. Sequenced genes were analyzed, and a phylogenetic tree was constructed using MEGA 6.0 with 1,000 bootstrap replications.
4 Discussion
In this study, 17 isolates were obtained and identified as Lpb. plantarum by physiological and biochemical experiments in vitro from Wuwei city’s local PLM in Anhui province. All the strains were safe for further use because no hemolysis ability was detected. The safety of LAB strains should be considered in the screening of probiotics, including identity and non-harmfulness activities. A previous study has illustrated that most of the LAB strains isolated from food showed γ-hemolysis [39]. The potential resistance gene to antibiotic is well-known to be genetically transferable [40]. Antibiotic resistance is an important issue to be considered in the process of isolating potential probiotics for safe application. All strains displayed multidrug resistance, which was considered to be the intrinsic, dependent, and endogenous resistance of LAB. Most LAB isolates were sensitive to erythromycin, but they were resistant to vancomycin due to their dependent and endogenous resistance to this drug [41]. The inherent resistance of Lpb. rhamnosus, Lpb. casei, Lpb. salivarius, and Lpb. plantarum to vancomycin was also reported [42]. The resistance to aminoglycoside antibiotics, such as streptomycin, kanamycin and gentamicin, is regarded to be an inherent characteristic of Lactiplantibacillus, as the absorption of antibiotic by lactobacilli is prevented by the absence of cytochrome-mediated electron transfer, leading to the resistance of LAB [30]. Among the 17 isolates in the present study, 9 exhibited sensitivity to most antibiotics. The results were in agreement with those of studies on the antibiotic sensitivity of LAB strains [30,34]. The development or selection of new beneficial microbes and their absence of cytotoxicity should be assessed. Although some LAB strains have been previously used for their technological properties or as probiotics for humans and animals, a case-by-case-evaluation is still needed [43]. Colorimetric analysis is based on the ability of viable cells to reduce a soluble yellow tetrazolium salt (MTT) to blue formazan crystals. In the present study, nine strains showed absence of cytotoxic activity on HT-29 cells, comparable with the cytotoxic activities as previously reported by Baccouri et al. [44] and Talebi et al. [29].
The adaptation of LAB strains to the environment with low pH and heavy bile salt concentration in the gastrointestinal tract and further survival are the preconditions for LAB [45]. At present, probiotics have been widely used in food and health industry, and their resistance to gastric acid and intestinal bile salt is very important for their application in this industry [46]. Lpb. plantarum Ln4 and G72 demonstrated obvious resistance to low pH environment after 24 h of incubation under the condition of artificial gastric juice [14]. The W. cibaria strain D29 displayed the highest resistance to artificial gastric juice and bile salt, with survival rates of 79.37 and 91.64% [47], respectively. Moreover, 18 strains survived after treatment with artificial gastrointestinal juices, and no significant difference in the number of viable cells was observed [30]. The results of the present study illustrated that six LAB strains showed enhanced resistance to artificially simulated gastrointestinal juices, similar to the conclusions on the tolerance to artificially simulated gastrointestinal juices of LAB strains as above. This finding may be attributed to the organic acid produced by LAB isolated from PLM during the fermentation process, and this organic acid could reduce the pH value of the growth environment. PLM is stored under a closed and cold environment to make the organic acid not easy to volatilize and maintain a stable pH value. The LAB isolates obtained from low pH condition in this study indicated that they could adapt to low pH condition and survive under extreme circumstances.
Antibacterial activity is an important selection criterion because of its prevention from potentially harmful intestinal microorganisms to guard against their colonization on the host intestinal mucosa [48,49]. Previous studies have confirmed that LAB have a wide spectrum of inhibition against pathogenic microbes, such as Salmonella, E. coli, Listeria, and Streptococcus [50]. The LAB from kimchi had a strong inhibitory effect on representative food-borne pathogens, such as E. coli, S. aureus, and S. enteric [47]. Moreover, Lpb. plantarum YS5, which was isolated from yogurt, exhibited excellent antibacterial ability on E. coli, S. aureus, and S. flexneri [37]. The present study showed that out of the six LAB strains, three possessed antibacterial activity against four indicator pathogens. Probiotics have been considered to exhibit their antibacterial activity by colonizing in the gastrointestinal tract and producing antibacterial substances that could inhibit pathogens [51]. These antimicrobial substances belong to different metabolites produced by LAB strains, including organic acids, hydrogen peroxide, and bacteriocins [52].
One of the key steps to determine the pathogenicity of intestinal pathogens is the ability to attach to the surface of intestinal epithelial cells through their fimbriae or pili, which grows on the surface of the pathogenic bacterial cells [53]. By co-culture with LAB, the colonization of intestinal pathogens on the surface of the intestinal epithelial cells could be reduced to prevent invasion of pathogens to the host. Lpb. plantarum DM69 displayed excellent ability to inhibit the intestinal adherence of pathogenic bacteria, and its inhibition rate on S. enterica was as high as 75% [32]. In addition, three probiotics, namely, Lactococcus lactis KC24, L. reuteri, and L. rhamnosus 3698, had the ability to effectively inhibit the intestinal adherence of Campylobacter jejuni and Helicobacter pylori [54]. Liu et al. [55] have reported that six LAB isolates strongly inhibited the intestinal adhesion of E. coli, and CCFM 233, with the highest adhesion ability, had the best inhibition rate on this intestinal adhesion. The results of the present study were basically consistent with the above conclusions about the inhibition of LAB on the intestinal adherence of pathogenic bacteria. Competitive rejection of pathogen adhesion to host cells by LAB has been considered as one of the important factors for LAB to inhibit pathogens [56]. The results suggested that AWP4, AWP7, and AWP11 possessed excellent intestinal adherence inhibition on the four indicator pathogens. Among them, AWP4 exhibited the highest intestinal adherence inhibition and the strongest antimicrobial effect on E. coli. Besides, AWP11 had not only the highest intestinal adherence inhibition but also the strongest antimicrobial ability on S. aureus and S. enterica, indicating that the antibacterial ability of this LAB strain basically had a positive correlation with the inhibition of intestinal adherence on the same pathogen in this work. However, further research should be employed to deeply explore the relationship and the underlying mechanism between the antibacterial activity and inhibition of intestinal adherence of LAB isolates.
The adhesion and colonization ability of LAB to the human intestinal wall is an important characteristic on the screening of probiotic strains, as the adhesion ability could contribute to prolonging the residence time of probiotic strains in the intestinal tract, which could enable them to play their own probiotic functions [57]. The adhesion capacity of microorganisms is a complex process of physical and chemical interaction between the surface of the microbe and the intestinal mucosa, including electrostatic interaction and cell-surface hydrophobicity [58,59]. Low co-aggregation of probiotics with pathogens may play an important role in preventing biofilm formation and reducing pathogen colonization. For instance, the Siamensis strain B44v derived from Thai pickled vegetables showed high auto-aggregation and hydrophobicity [60]. The mucin binding rate of B44v reached 88.7%. The cell-surface hydrophobicity to n-hexadecane and xylene of LAB strains, including PUFSTP 35, PUFSTP 38, PUFSTP 44, and PUFSTP 74, isolated from the traditional brine pickle was high [61]; the hydrophobicity to n-hexadecane of LAB originating from traditional pickles was the strongest at 97.96, 82.41, 67.29, and 62.36% [62], respectively. Moreover, the hydrophobicity difference was significant at the species level. All the three selected LAB strains in the present study displayed different degrees of hydrophobicity (40.80–54.27%), auto-aggregation (30.39–48.78%), co-aggregation (1.56–33.13%), and mucin binding ability (49.70–63.81%). The binding to host intestinal mucin is helpful for the colonization of LAB in the intestine [63]. The different degrees of interaction between mucin and the glycochain molecule was the main reason for the different mucin binding abilities of LAB [64].
The oxygen radicals produced in the body damage the biological macromolecules, and probiotics with antioxidant activity could protect the host from peroxidation by neutralizing the radicals [29]. It also contributes to the prevention of cardiovascular disease, diabetes, and gastrointestinal ulcer [65]. Determining the DPPH radical scavenging ability is one of the important methods to investigate the antioxidant activity of probiotics. ABTS+ belongs to a kind of colorless radical that could dissolve in organic or water phase and react with an antioxidant [66]. Hydroxyl radical, with the strongest chemical activity among the active oxygen radicals, could cause peroxide damage on proteins, lipids, DNA, and other macromolecules. Therefore, hydroxyl radical scavenging may be one of the most effective measures to resist the invasion of various diseases [67]. Yang et al. [68] determined the scavenging ability of strain JR14 isolated from Chinese traditional fermented pickles to have a hydroxyl radical of 1535.18 μmol L−1 in terms of Trolox equivalents. The results of other research studies presented that PUFSTP71, PUFSTP 39, and PUFSTP81 exhibited high DPPH scavenging ability (517.55 μmol L−1), excellent ABTS+ radical scavenging ability (655.54 μmol L−1), and good hydroxyl radical scavenging ability (1689.00 μmol L−1) [66], respectively. The DPPH radical scavenging rate of Lpb. plantarum Ln4 screened from kimchi reached 662.39 μmol L−1 [14]. The scavenging ability to hydroxyl and DPPH radical of Lpb. plantarum DM5 was 1800.44 and 912.03 μmol L−1 in terms of Trolox equivalents [69], respectively. The present study showed that AWP4 also possessed antioxidant activity similar to the above results. AWP4 displayed better antioxidant activity than the other two strains, which may be attributed to its excellent protection mechanism from the oxidative damage of hydroxyl radicals and other ROS [69]. Probiotic fermentation is also a good antioxidant method compared with scavenging hydroxyl radical by chelating metal ions with some antioxidants [70].
Combined with the colony morphological characteristics and phylogenetic analysis of 16S rRNA gene, AWP4 was identified as Lpb. plantarum. Diabetes mellitus is a kind of metabolic disease characterized by hyperglycemia, which has already become a worldwide medical problem. If not properly managed, it could lead to chronic damage and dysfunction of various tissues, especially eyes, kidney, heart, blood vessels, and nerves. Using α-amylase inhibitor as a hypoglycemic agent to slow the digestion and absorption of starch and reduce postprandial hyperglycemia could treat diabetes mellitus [71]. However, various side effects, such as diarrhea, abdominal distention, and flatulence, have been reported with the use of synthetase inhibitors [72]. Screening safe and healthy enzyme inhibitors without side effects or with fewer negative effects has become a new direction of research on enzyme inhibitors. Therefore, the inhibition of α-amylase activity is one of the important indices to assess the potential probiotic activity. In the present study, the α-amylase activity inhibition ratio of AWP4 was significantly higher than that of LGG.
The cholesterol assimilation ability of LAB is an important parameter in screening probiotic strains with healthcare functions [50]. Lpb. plantarum strain YS5 showed a strong effect on lowering sera cholesterol level with high cholesterol scavenging capacity [37]. Lpb. plantarum FB003 possessed the highest cholesterol clearance rate of 43.1% [50]. Sharma et al. [63] have reported that the cholesterol clearance rate of Lpb. plantarum K90 was up to 75%. In the present study, AWP4 also displayed better cholesterol assimilation ability than that in previous studies. The cholesterol scavenging ability of probiotics may be due to the assimilation and binding of cholesterol on the surface of probiotic cells, eventually resulting in the coprecipitation of cholesterol [73]. In addition, the combination of cholesterol with the cell wall of probiotics or the physiological function of the end products of short chain fatty acid fermentation was related to the cholesterol assimilation ability of probiotics [74]. Lambert et al. [75] have proposed that the cholesterol assimilation ability of probiotics was related to the bile salt hydrolytic enzyme (BSH) of probiotics, especially the interference of intestinal absorption micelle formation and BSH activity.
5 Conclusion
This study was the first to isolate potential probiotic candidates from Wuwei city’s local PLM in Anhui province and further evaluate their potential probiotic activities as substitutes for chemical synthetic additives. A total of 17 strains were obtained from PLM and tested for safety, good resistance to artificial simulated gastrointestinal juices, antibacterial activity on common gastrointestinal pathogens, inhibition of intestinal adherence of pathogen bacteria, and adhesion capacities. AWP4 (Lpb. plantarum) exhibited remarkable antioxidant activity. It also possessed good probiotic and healthcare functions, including inhibition of α-amylase activity and cholesterol assimilation ability. The data illustrated that AWP4 is a satisfactory probiotic candidate, and it could be used not only in food fermentation but also in industrial additives. However, further animal experiments should be carried out to evaluate the probiotic effect and safety of AWP4 in vivo.
Acknowledgments
The authors thank anonymous reviewers for their helpful comments and suggestions to improve this manuscript.
-
Funding information: This work was supported by the “13th Five-Year Plan” Key Medical and Health Specialty of Anhui ([2017] 30) and the Scientific Research Program of Anhui Health and Family Planning Commission (2018YK007).
-
Author contributions: W.C.J.: data curation, formal analysis, investigation, and writing – original draft; L.X.P.: data curation and investigation; T.L.: investigation and methodology; D.C.W.: data curation and investigation; L.H.: data curation and investigation; Z.X.H.: conceptualization, writing – original draft and writing – review and editing; Z.J.: conceptualization, supervision, and writing – review and editing.
-
Conflict of interest: All authors declare no competing interests.
-
Data availability statement: All data generated or analyzed during this study are included in this article. All authors make sure that all data and materials as well as software application or custom code support their published claims and comply with field standards.
References
[1] Castro MP, Palavecino NZ, Herman C, Garro OA, Campos CA. Lactic acid bacteria isolated from artisanal dry sausages: characterization of antibacterial compounds and study of the factors affecting bacteriocin production. Meat Sci. 2011;87:321–9.10.1016/j.meatsci.2010.11.006Search in Google Scholar PubMed
[2] Speranza B, Racioppo A, Beneduce L, Bevilacqua A, Sinigaglia M, Corbo MR. Autochthonous lactic acid bacteria with probiotic aptitudes as starter cultures for fish-based products. Food Microbiol. 2017;65:244–53.10.1016/j.fm.2017.03.010Search in Google Scholar PubMed
[3] Şanlidere Aloğlu H, Demir Özer E, Öner Z. Assimilation of cholesterol and probiotic characterisation of yeast strains isolated from raw milk and fermented foods. Int J Dairy Technol. 2016;69:63–70.10.1111/1471-0307.12217Search in Google Scholar
[4] Mizock BA. Probiotics. Dis Mon. 2015;61:259–90.10.1016/j.disamonth.2015.03.011Search in Google Scholar PubMed
[5] Wang J, Han M, Zhang G, Qiao S, Li D, Ma X. The signal pathway of antibiotic alternatives on intestinal microbiota and immune function. Curr Protein Pept Sci. 2016;17:785–96.10.2174/1389203717666160526123351Search in Google Scholar PubMed
[6] Hossain MI, Sadekuzzaman M, Ha SD. Probiotics as potential alternative biocontrol agents in the agriculture and food industries: a review. Food Res Int. 2017;100:63–73.10.1016/j.foodres.2017.07.077Search in Google Scholar PubMed
[7] Argyri AA, Zoumpopoulou G, Karatzas KA, Tsakalidou E, Nychas GJ, Panagou EZ, et al. Selection of potential probiotic lactic acid bacteria from fermented olives by in vitro tests. Food Microbiol. 2013;33:282–91.10.1016/j.fm.2012.10.005Search in Google Scholar PubMed
[8] Kanmani P, Satish Kumar R, Yuvaraj N, Paari KA, Pattukumar V, Arul V. Probiotics and its functionally valuable products – a review. Crit Rev Food Sci Nutr. 2013;53:641–58.10.1080/10408398.2011.553752Search in Google Scholar PubMed
[9] Altay F, Karbancıoglu-Güler F, Daskaya-Dikmen C, Heperkan D. A review on traditional Turkish fermented non-alcoholic beverages: microbiota, fermentation process and quality characteristics. Int J Food Microbiol. 2013;167:44–56.10.1016/j.ijfoodmicro.2013.06.016Search in Google Scholar PubMed
[10] Cao Z, Pan H, Tong H, Gu D, Li S, Xu Y, et al. In vitro evaluation of probiotic potential of Pediococcus pentosaceus L1 isolated from paocai-a Chinese fermented vegetable. Ann Microbiol. 2016;66:963–71.10.1007/s13213-015-1182-2Search in Google Scholar
[11] Cebeci A, Gürakan C. Properties of potential probiotic Lactobacillus plantarum strains. Food Microbiol. 2003;20:511–8.10.1016/S0740-0020(02)00174-0Search in Google Scholar
[12] García-Ruiz A, González de Llano D, Esteban-Fernández A, Requena T, Bartolomé B, Moreno-Arribas MV. Assessment of probiotic properties in lactic acid bacteria isolated from wine. Food Microbiol. 2014;44:220–5.10.1016/j.fm.2014.06.015Search in Google Scholar PubMed
[13] Karasu N, Şimşek Ö, Çon AH. Technological and probiotic characteristics of Lactobacillus plantarum strains isolated from traditionally produced fermented vegetables. Ann Microbiol. 2010;60:227–34.10.1007/s13213-010-0031-6Search in Google Scholar
[14] Son SH, Jeon HL, Jeon EB, Lee NK, Park YS, Kang DK, et al. Potential probiotic Lactobacillus plantarum Ln4 from kimchi: evaluation of β-galactosidase and antioxidant activities. LWT-Food Sci Technol. 2017;85:181–6.10.1016/j.lwt.2017.07.018Search in Google Scholar
[15] Zhao W, Gu CT. Lactobacillus hulanensis sp. nov., isolated from suancai, a traditional Chinese pickle. Int J Syst Evolut Microbiol. 2019;69:2147–52.10.1099/ijsem.0.003453Search in Google Scholar PubMed
[16] Zhu K, Tan F, Mu J, Yi R, Zhou X, Zhao X. Anti-obesity effects of Lactobacillus fermentum CQPC05 isolated from sichuan pickle in high-fat diet-induced obese mice through PPAR-α signaling pathway. Microorganisms. 2019;7:194.10.3390/microorganisms7070194Search in Google Scholar PubMed PubMed Central
[17] Yu HS, Lee NK, Choi AJ, Choe JS, Bae CH, Paik HD. Antagonistic and antioxidant effect of probiotic Weissella cibaria JW15. Food Sci Biotechnol. 2019;28:851–5.10.1007/s10068-018-0519-6Search in Google Scholar PubMed PubMed Central
[18] Ooi LG, Liong MT. Cholesterol-lowering effects of probiotics and prebiotics: a review of in vivo and in vitro findings. Int J Mol Sci. 2010;11:2499–522.10.3390/ijms11062499Search in Google Scholar PubMed PubMed Central
[19] Kumar A, Kumar D. Characterization of Lactobacillus isolated from dairy samples for probiotic properties. Anaerobe. 2015;33:117–23.10.1016/j.anaerobe.2015.03.004Search in Google Scholar PubMed
[20] And CI, Kailasapathy K. Effect of co-encapsulation of probiotics with prebiotics on increasing the viability of encapsulated bacteria under in vitro acidic and bile salt conditions and in yogurt. J Food Sci. 2005;70:M18–23.10.1111/j.1365-2621.2005.tb09041.xSearch in Google Scholar
[21] Aswathy RG, Ismail B, John RP, Nampoothiri KM. Evaluation of the probiotic characteristics of newly isolated lactic acid bacteria. Appl Biochem Biotechnol. 2008;151:244–55.10.1007/s12010-008-8183-6Search in Google Scholar PubMed
[22] Lee NK, Han K, Son SH, Eom S, Lee SK, Paik HD. Multifunctional effect of probiotic Lactococcus lactis KC24 isolated from kimchi. LWT-Food Sci Technol. 2015;64:1036–41.10.1016/j.lwt.2015.07.019Search in Google Scholar
[23] Uttara B, Singh AV, Zamboni P, Mahajan RT. Oxidative stress and neurodegenerative diseases: a review of upstream and downstream antioxidant therapeutic options. Curr Neuropharmacol. 2009;7:65–74.10.2174/157015909787602823Search in Google Scholar PubMed PubMed Central
[24] Piyadeatsoontorn S, Taharnklaew R, Upathanpreecha T, Sornplang P. Encapsulating viability of multi-strain Lactobacilli as potential probiotic in pigs. Probiotics Antimicrob Proteins. 2019;11:438–46.10.1007/s12602-018-9418-7Search in Google Scholar PubMed
[25] Menezes AGT, Ramos CL, Cenzi G, Melo DS, Dias DR, Schwan RF. Probiotic potential, antioxidant activity, and phytase production of indigenous yeasts isolated from indigenous fermented foods. Probiotics Antimicrob Proteins. 2020;12:280–8.10.1007/s12602-019-9518-zSearch in Google Scholar PubMed
[26] Pieniz S, Andreazza R, Anghinoni T, Camargo F, Brandelli A. Probiotic potential, antimicrobial and antioxidant activities of Enterococcus durans strain LAB18s. Food Control. 2014;37:251–6.10.1016/j.foodcont.2013.09.055Search in Google Scholar
[27] Maldonado NC, de Ruiz CS, Otero MC, Sesma F, Nader-Macías ME. Lactic acid bacteria isolated from young calves-characterization and potential as probiotics. Res Vet Sci. 2012;92:342–9.10.1016/j.rvsc.2011.03.017Search in Google Scholar PubMed
[28] Cockerill FR, Wikler MA, Alder J, Dudley MN, Eliopoulos GM. Performance standards for antimicrobial susceptibility testing. Twenty-second informational supplement. Wayne, PA, USA: Clinical and Laboratory Standards Institute (CLSI); 2012.Search in Google Scholar
[29] Talebi S, Makhdoumi A, Bahreini M, Matin MM, Moradi HS. Three novel Bacillus strains from a traditional lacto-fermented pickle as potential probiotics. J Appl Microbiol. 2018;125:888–96.10.1111/jam.13901Search in Google Scholar PubMed
[30] Cao Z, Pan H, Li S, Shi C, Wang S, Wang F, et al. In vitro evaluation of probiotic potential of lactic acid bacteria isolated from yunnan de’ang pickled tea. Probiotics Antimicrob Proteins. 2019;11:103–12.10.1007/s12602-018-9395-xSearch in Google Scholar PubMed
[31] Iraporda C, Rubel IA, Manrique GD, Abraham AG. Influence of inulin rich carbohydrates from Jerusalem artichoke (Helianthus tuberosus L.) tubers on probiotic properties of Lactobacillus strains. LWT. 2018;101:738–46.10.1016/j.lwt.2018.11.074Search in Google Scholar
[32] Mohanty D, Panda S, Kumar S, Ray P. In vitro evaluation of adherence and anti-infective property of probiotic Lactobacillus plantarum DM 69 against Salmonella enterica. Microb Pathog. 2019;126:212–7.10.1016/j.micpath.2018.11.014Search in Google Scholar PubMed
[33] Zhang Y, Zhang L, Du M, Yi H, Guo C, Tuo Y, et al. Antimicrobial activity against Shigella sonnei and probiotic properties of wild lactobacilli from fermented food. Microbiol Res. 2011;167:27–31.10.1016/j.micres.2011.02.006Search in Google Scholar PubMed
[34] Niu KM, Kothari D, Cho SB, Han SG, Song IG, Kim SC, et al. Exploring the probiotic and compound feed fermentative applications of Lactobacillus plantarum SK1305 isolated from korean green chili pickled pepper. Probiotics Antimicrob Proteins. 2019;11:801–12.10.1007/s12602-018-9447-2Search in Google Scholar PubMed
[35] Monteiro C, do Carmo MS, Melo BO, Alves MS, Dos Santos CI, Monteiro SG, et al. In vitro antimicrobial activity and probiotic potential of Bifidobacterium and Lactobacillus against species of Clostridium. Nutrients. 2019;11:448.10.3390/nu11020448Search in Google Scholar PubMed PubMed Central
[36] Tang W, Xing Z, Li C, Wang J, Wang Y. Molecular mechanisms and in vitro antioxidant effects of Lactobacillus plantarum MA2. Food Chem. 2017;221:1642–9.10.1016/j.foodchem.2016.10.124Search in Google Scholar PubMed
[37] Nami Y, Vaseghi Bakhshayesh R, Manafi M, Hejazi MA. Hypocholesterolaemic activity of a novel autochthonous potential probiotic Lactobacillus plantarum YS5 isolated from yogurt. LWT-Food Sci Technol. 2019;111:876–82.10.1016/j.lwt.2019.05.057Search in Google Scholar
[38] Xia Y, Qin S, Shen Y. Probiotic potential of Weissella strains isolated from horse feces. Microb Pathog. 2019;132:117–23.10.1016/j.micpath.2019.04.032Search in Google Scholar PubMed
[39] Kumar A. Isolation of Lactobacillus plantarum from cow milk and screening for the presence of sugar alcohol producing gene. J Microbiol Antimicrob. 2012;4:16–22.10.5897/JMA11.083Search in Google Scholar
[40] Borriello S, Hammes W, Marteau P, Schrezenmeir J, Vaara M, Valtonen V. Safety of probiotics that contain Lactobacilli or Bifidobacteria. Clin Infect Dis. 2003;36:775–80.10.1086/368080Search in Google Scholar PubMed
[41] Delgado S, Flórez AB, Mayo B. Antibiotic susceptibility of Lactobacillus and Bifidobacterium species from the human gastrointestinal tract. Curr Microbiol. 2005;50:202–7.10.1007/s00284-004-4431-3Search in Google Scholar PubMed
[42] Milazzo I, Speciale A, Musumeci R, Fazio D, Blandino G. Identification and antibiotic susceptibility of bacterial isolates from probiotic products available in Italy. New Microbiol. 2006;29:281–91.Search in Google Scholar
[43] Hanchi H, Mottawea W, Sebei K, Hammami R. The genus Enterococcus: between probiotic potential and safety concerns-an update. Front Microbiol. 2018;9:1791.10.3389/fmicb.2018.01791Search in Google Scholar PubMed PubMed Central
[44] Baccouri O, Boukerb AM, Farhat LB, Zébré A, Zimmermann K, Domann E, et al. Probiotic potential and safety evaluation of Enterococcus faecalis OB14 and OB15, isolated from traditional tunisian testouri cheese and rigouta, using physiological and genomic analysis. Front Microbiol. 2019;10:881.10.3389/fmicb.2019.00881Search in Google Scholar
[45] Czerucka D, Piche T, Rampal P. Review article: yeast as probiotics – Saccharomyces boulardii. Aliment Pharmacol Therapeut. 2007;26:767–78.10.1111/j.1365-2036.2007.03442.xSearch in Google Scholar
[46] Chalas R, Janczarek M, Bachanek T, Mazur E, Cieszko-Buk M, Szymanska J. Characteristics of oral probiotics – a review. Curr Issues Pharm Medical Sci. 2016;29:8–10.10.1515/cipms-2016-0002Search in Google Scholar
[47] Yu HS, Jang HJ, Lee NK, Paik HD. Evaluation of the probiotic characteristics and prophylactic potential of Weissella cibaria strains isolated from kimchi. LWT. 2019;112:108229.10.1016/j.lwt.2019.05.127Search in Google Scholar
[48] Papamanoli E, Tzanetakis N, Litopoulou-Tzanetaki E, Kotzekidou P. Characterization of lactic acid bacteria isolated from a Greek dry-fermented sausage in respect of their technological and probiotic properties. Meat Sci. 2003;65:859–67.10.1016/S0309-1740(02)00292-9Search in Google Scholar
[49] Gheziel C, Russo P, Arena MP, Spano G, Ouzari HI, Kheroua O, et al. Evaluating the probiotic potential of Lactobacillus plantarum strains from algerian infant feces: towards the design of probiotic starter cultures tailored for developing countries. Probiotics Antimicrob Proteins. 2019;11:113–23.10.1007/s12602-018-9396-9Search in Google Scholar PubMed
[50] Le B, Yang SH. Identification of a novel potential probiotic Lactobacillus plantarum FB003 isolated from salted-fermented shrimp and its effect on cholesterol absorption by regulation of NPC1L1 and PPARα. Probiotics Antimicrob Proteins. 2019;11:785–93.10.1007/s12602-018-9469-9Search in Google Scholar PubMed
[51] Ramos CL, Thorsen L, Schwan RF, Jespersen L. Strain-specific probiotics properties of Lactobacillus fermentum, Lactobacillus plantarum and Lactobacillus brevis isolates from Brazilian food products. Food Microbiol. 2013;36:22–9.10.1016/j.fm.2013.03.010Search in Google Scholar PubMed
[52] Espeche MC, Pellegrino M, Frola I, Larriestra A, Bogni C, Nader-Macías ME. Lactic acid bacteria from raw milk as potentially beneficial strains to prevent bovine mastitis. Anaerobe. 2012;18:103–9.10.1016/j.anaerobe.2012.01.002Search in Google Scholar PubMed
[53] Weinstein DL, O’Neill BL, Hone DM, Metcalf ES. Differential early interactions between Salmonella enterica serovar Typhi and two other pathogenic Salmonella serovars with intestinal epithelial cells. Infect Immun. 1998;66:2310–8.10.1128/IAI.66.5.2310-2318.1998Search in Google Scholar PubMed PubMed Central
[54] Mukai T, Asasaka T, Sato E, Mori K, Matsumoto M, Ohori H. Inhibition of binding of Helicobacter pylori to the glycolipid receptors by probiotic Lactobacillus reuteri. FEMS Immunol Med Microbiol. 2002;32:105–10.10.1111/j.1574-695X.2002.tb00541.xSearch in Google Scholar PubMed
[55] Liu X, Liu W, Zhang Q, Tian F, Wang G, Zhang H, et al. Screening of lactobacilli with antagonistic activity against enteroinvasive Escherichia coli. Food Control. 2013;30:563–8.10.1016/j.foodcont.2012.09.002Search in Google Scholar
[56] Gueimonde M, Jalonen L, He F, Hiramatsu M, Salminen S. Adhesion and competitive inhibition and displacement of human enteropathogens by selected lactobacilli. Food Res Int. 2006;39:467–71.10.1016/j.foodres.2005.10.003Search in Google Scholar
[57] Kechagia M, Basoulis D, Konstantopoulou S, Dimitriadi D, Gyftopoulou K, Skarmoutsou N, et al. Health benefits of probiotics: a review. ISRN Nutr. 2013;2013:481651.10.5402/2013/481651Search in Google Scholar PubMed PubMed Central
[58] Collado MC, Meriluoto J, Salminen S. Adhesion and aggregation properties of probiotic and pathogen strains. Eur Food Res Technol. 2008;226:1065–73.10.1007/s00217-007-0632-xSearch in Google Scholar
[59] García-Cayuela T, Korany AM, Bustos IP, Gómez de Cadiñanos L, Requena T, Peláez C, et al. Adhesion abilities of dairy Lactobacillus plantarum strains showing an aggregation phenotype. Food Res Int. 2014;57:44–50.10.1016/j.foodres.2014.01.010Search in Google Scholar
[60] Meidong R, Doolgindachbaporn S, Jamjan W, Sakai K, Tashiro Y, Okugawa Y, et al. A novel probiotic Bacillus siamensis B44v isolated from Thai pickled vegetables (Phak-dong) for potential use as a feed supplement in aquaculture. J Gen Appl Microbiol. 2017;63:246–53.10.2323/jgam.2016.12.002Search in Google Scholar PubMed
[61] Ragul K, Syiem I, Sundar K, Shetty PH. Characterization of probiotic potential of Bacillus species isolated from a traditional brine pickle. J Food Sci Technol. 2017;54:4473–83.10.1007/s13197-017-2928-6Search in Google Scholar PubMed PubMed Central
[62] Tokatlı M, Gülgör G, Bağder Elmacı S, Arslankoz İşleyen N, Özçelik F. In vitro properties of potential probiotic indigenous lactic acid bacteria originating from traditional pickles. Biomed Res Int. 2015;2015:315819.10.1155/2015/315819Search in Google Scholar PubMed PubMed Central
[63] Sharma K, Attri S, Goel G. Selection and evaluation of probiotic and functional characteristics of autochthonous lactic acid bacteria isolated from fermented wheat flour dough babroo. Probiotics Antimicrob Proteins. 2019;11:774–84.10.1007/s12602-018-9466-zSearch in Google Scholar PubMed
[64] Korcz E, Kerényi Z, Varga L. Dietary fibers, prebiotics, and exopolysaccharides produced by lactic acid bacteria: potential health benefits with special regard to cholesterol-lowering effects. Food Funct. 2018;9:3057–68.10.1039/C8FO00118ASearch in Google Scholar
[65] Kaushik JK, Kumar A, Duary RK, Mohanty AK, Grover S, Batish VK. Functional and probiotic attributes of an indigenous isolate of Lactobacillus plantarum. PLoS One. 2009;4:e8099.10.1371/journal.pone.0008099Search in Google Scholar PubMed PubMed Central
[66] Ragul K, Kandasamy S, Devi PB, Shetty PH. Evaluation of functional properties of potential probiotic isolates from fermented brine pickle. Food Chem. 2020;311:126057.10.1016/j.foodchem.2019.126057Search in Google Scholar PubMed
[67] Cui C, Hu Q, Ren J, Zhao M, Du H. The effect of lactic acid bacteria fermentation on the antioxidant activity of wheat gluten pancreatin hydrolysates. Int J Food Sci Technol. 2014;49:1048–54.10.1111/ijfs.12399Search in Google Scholar
[68] Yang M, Jiang R, Liu M, Chen S, He L, Ao X, et al. Study of the probiotic properties of lactic acid bacteria isolated from Chinese traditional fermented pickles. J Food Process Preservat. 2017;41:e12954.10.1111/jfpp.12954Search in Google Scholar
[69] Das D, Goyal A. Antioxidant activity and γ-aminobutyric acid (GABA) producing ability of probiotic Lactobacillus plantarum DM5 isolated from Marcha of Sikkim. LWT-Food Sci Technol. 2015;61:263–8.10.1016/j.lwt.2014.11.013Search in Google Scholar
[70] Li S, Zhao Y, Zhang L, Zhang X, Huang L, Li D, et al. Antioxidant activity of Lactobacillus plantarum strains isolated from traditional Chinese fermented foods. Food Chem. 2012;135:1914–9.10.1016/j.foodchem.2012.06.048Search in Google Scholar PubMed
[71] Jong-Anurakkun N, Bhandari MR, Kawabata J. α-Glucosidase inhibitors from Devil tree (Alstonia scholaris). Food Chem. 2007;103:1319–23.10.1016/j.foodchem.2006.10.043Search in Google Scholar
[72] Abirami A, Nagarani G, Siddhuraju P. In vitro antioxidant, anti-diabetic, cholinesterase and tyrosinase inhibitory potential of fresh juice from Citrus hystrix and C. maxima fruits. Food Sci Human Wellness. 2014;3:16–25.10.1016/j.fshw.2014.02.001Search in Google Scholar
[73] Lye HS, Rusul G, Liong MT. Mechanisms of cholesterol removal by Lactoballi under conditions that mimic the human gastrointestinal tract. Int Dairy J. 2010;20:169–75.10.1016/j.idairyj.2009.10.003Search in Google Scholar
[74] Kumar M, Nagpal R, Kumar R, Hemalatha R, Verma V, Kumar A, et al. Cholesterol-lowering probiotics as potential biotherapeutics for metabolic diseases. Exp Diabet Res. 2012;2012:902917.10.1155/2012/902917Search in Google Scholar PubMed PubMed Central
[75] Lambert JM, Bongers RS, de Vos WM, Kleerebezem M. Functional analysis of four bile salt hydrolase and penicillin acylase family members in Lactobacillus plantarum WCFS1. Appl Environ Microbiol. 2008;74:4719–26.10.1128/AEM.00137-08Search in Google Scholar PubMed PubMed Central
© 2021 Changjun Wu et al., published by De Gruyter
This work is licensed under the Creative Commons Attribution 4.0 International License.
Articles in the same Issue
- Regular Articles
- Qualitative and semi-quantitative assessment of anthocyanins in Tibetan hulless barley from different geographical locations by UPLC-QTOF-MS and their antioxidant capacities
- Effect of sodium chloride on the expression of genes involved in the salt tolerance of Bacillus sp. strain “SX4” isolated from salinized greenhouse soil
- GC-MS analysis of mango stem bark extracts (Mangifera indica L.), Haden variety. Possible contribution of volatile compounds to its health effects
- Influence of nanoscale-modified apatite-type calcium phosphates on the biofilm formation by pathogenic microorganisms
- Removal of paracetamol from aqueous solution by containment composites
- Investigating a human pesticide intoxication incident: The importance of robust analytical approaches
- Induction of apoptosis and cell cycle arrest by chloroform fraction of Juniperus phoenicea and chemical constituents analysis
- Recovery of γ-Fe2O3 from copper ore tailings by magnetization roasting and magnetic separation
- Effects of different extraction methods on antioxidant properties of blueberry anthocyanins
- Modeling the removal of methylene blue dye using a graphene oxide/TiO2/SiO2 nanocomposite under sunlight irradiation by intelligent system
- Antimicrobial and antioxidant activities of Cinnamomum cassia essential oil and its application in food preservation
- Full spectrum and genetic algorithm-selected spectrum-based chemometric methods for simultaneous determination of azilsartan medoxomil, chlorthalidone, and azilsartan: Development, validation, and application on commercial dosage form
- Evaluation of the performance of immunoblot and immunodot techniques used to identify autoantibodies in patients with autoimmune diseases
- Computational studies by molecular docking of some antiviral drugs with COVID-19 receptors are an approach to medication for COVID-19
- Synthesis of amides and esters containing furan rings under microwave-assisted conditions
- Simultaneous removal efficiency of H2S and CO2 by high-gravity rotating packed bed: Experiments and simulation
- Design, synthesis, and biological activities of novel thiophene, pyrimidine, pyrazole, pyridine, coumarin and isoxazole: Dydrogesterone derivatives as antitumor agents
- Content and composition analysis of polysaccharides from Blaps rynchopetera and its macrophage phagocytic activity
- A new series of 2,4-thiazolidinediones endowed with potent aldose reductase inhibitory activity
- Assessing encapsulation of curcumin in cocoliposome: In vitro study
- Rare norisodinosterol derivatives from Xenia umbellata: Isolation and anti-proliferative activity
- Comparative study of antioxidant and anticancer activities and HPTLC quantification of rutin in white radish (Raphanus sativus L.) leaves and root extracts grown in Saudi Arabia
- Comparison of adsorption properties of commercial silica and rice husk ash (RHA) silica: A study by NIR spectroscopy
- Sodium borohydride (NaBH4) as a high-capacity material for next-generation sodium-ion capacitors
- Aroma components of tobacco powder from different producing areas based on gas chromatography ion mobility spectrometry
- The effects of salinity on changes in characteristics of soils collected in a saline region of the Mekong Delta, Vietnam
- Synthesis, properties, and activity of MoVTeNbO catalysts modified by zirconia-pillared clays in oxidative dehydrogenation of ethane
- Synthesis and crystal structure of N,N′-bis(4-chlorophenyl)thiourea N,N-dimethylformamide
- Quantitative analysis of volatile compounds of four Chinese traditional liquors by SPME-GC-MS and determination of total phenolic contents and antioxidant activities
- A novel separation method of the valuable components for activated clay production wastewater
- On ve-degree- and ev-degree-based topological properties of crystallographic structure of cuprite Cu2O
- Antihyperglycemic effect and phytochemical investigation of Rubia cordifolia (Indian Madder) leaves extract
- Microsphere molecularly imprinted solid-phase extraction for diazepam analysis using itaconic acid as a monomer in propanol
- A nitric oxide-releasing prodrug promotes apoptosis in human renal carcinoma cells: Involvement of reactive oxygen species
- Machine vision-based driving and feedback scheme for digital microfluidics system
- Study on the application of a steam-foam drive profile modification technology for heavy oil reservoir development
- Ni–Ru-containing mixed oxide-based composites as precursors for ethanol steam reforming catalysts: Effect of the synthesis methods on the structural and catalytic properties
- Preparation of composite soybean straw-based materials by LDHs modifying as a solid sorbent for removal of Pb(ii) from water samples
- Synthesis and spectral characterizations of vanadyl(ii) and chromium(iii) mixed ligand complexes containing metformin drug and glycine amino acid
- In vitro evaluation of lactic acid bacteria with probiotic activity isolated from local pickled leaf mustard from Wuwei in Anhui as substitutes for chemical synthetic additives
- Utilization and simulation of innovative new binuclear Co(ii), Ni(ii), Cu(ii), and Zn(ii) diimine Schiff base complexes in sterilization and coronavirus resistance (Covid-19)
- Phosphorylation of Pit-1 by cyclin-dependent kinase 5 at serine 126 is associated with cell proliferation and poor prognosis in prolactinomas
- Molecularly imprinted membrane for transport of urea, creatinine, and vitamin B12 as a hemodialysis candidate membrane
- Optimization of Murrayafoline A ethanol extraction process from the roots of Glycosmis stenocarpa, and evaluation of its Tumorigenesis inhibition activity on Hep-G2 cells
- Highly sensitive determination of α-lipoic acid in pharmaceuticals on a boron-doped diamond electrode
- Synthesis, chemo-informatics, and anticancer evaluation of fluorophenyl-isoxazole derivatives
- In vitro and in vivo investigation of polypharmacology of propolis extract as anticancer, antibacterial, anti-inflammatory, and chemical properties
- Topological indices of bipolar fuzzy incidence graph
- Preparation of Fe3O4@SiO2–ZnO catalyst and its catalytic synthesis of rosin glycol ester
- Construction of a new luminescent Cd(ii) compound for the detection of Fe3+ and treatment of Hepatitis B
- Investigation of bovine serum albumin aggregation upon exposure to silver(i) and copper(ii) metal ions using Zetasizer
- Discoloration of methylene blue at neutral pH by heterogeneous photo-Fenton-like reactions using crystalline and amorphous iron oxides
- Optimized extraction of polyphenols from leaves of Rosemary (Rosmarinus officinalis L.) grown in Lam Dong province, Vietnam, and evaluation of their antioxidant capacity
- Synthesis of novel thiourea-/urea-benzimidazole derivatives as anticancer agents
- Potency and selectivity indices of Myristica fragrans Houtt. mace chloroform extract against non-clinical and clinical human pathogens
- Simple modifications of nicotinic, isonicotinic, and 2,6-dichloroisonicotinic acids toward new weapons against plant diseases
- Synthesis, optical and structural characterisation of ZnS nanoparticles derived from Zn(ii) dithiocarbamate complexes
- Presence of short and cyclic peptides in Acacia and Ziziphus honeys may potentiate their medicinal values
- The role of vitamin D deficiency and elevated inflammatory biomarkers as risk factors for the progression of diabetic nephropathy in patients with type 2 diabetes mellitus
- Quantitative structure–activity relationship study on prolonged anticonvulsant activity of terpene derivatives in pentylenetetrazole test
- GADD45B induced the enhancing of cell viability and proliferation in radiotherapy and increased the radioresistance of HONE1 cells
- Cannabis sativa L. chemical compositions as potential plasmodium falciparum dihydrofolate reductase-thymidinesynthase enzyme inhibitors: An in silico study for drug development
- Dynamics of λ-cyhalothrin disappearance and expression of selected P450 genes in bees depending on the ambient temperature
- Identification of synthetic cannabinoid methyl 2-{[1-(cyclohexylmethyl)-1H-indol-3-yl] formamido}-3-methylbutanoate using modern mass spectrometry and nuclear magnetic resonance techniques
- Study on the speciation of arsenic in the genuine medicinal material honeysuckle
- Two Cu(ii)-based coordination polymers: Crystal structures and treatment activity on periodontitis
- Conversion of furfuryl alcohol to ethyl levulinate in the presence of mesoporous aluminosilicate catalyst
- Review Articles
- Hsien Wu and his major contributions to the chemical era of immunology
- Overview of the major classes of new psychoactive substances, psychoactive effects, analytical determination and conformational analysis of selected illegal drugs
- An overview of persistent organic pollutants along the coastal environment of Kuwait
- Mechanism underlying sevoflurane-induced protection in cerebral ischemia–reperfusion injury
- COVID-19 and SARS-CoV-2: Everything we know so far – A comprehensive review
- Challenge of diabetes mellitus and researchers’ contributions to its control
- Advances in the design and application of transition metal oxide-based supercapacitors
- Color and composition of beauty products formulated with lemongrass essential oil: Cosmetics formulation with lemongrass essential oil
- The structural chemistry of zinc(ii) and nickel(ii) dithiocarbamate complexes
- Bioprospecting for antituberculosis natural products – A review
- Recent progress in direct urea fuel cell
- Rapid Communications
- A comparative morphological study of titanium dioxide surface layer dental implants
- Changes in the antioxidative properties of honeys during their fermentation
- Erratum
- Erratum to “Corrosion study of copper in aqueous sulfuric acid solution in the presence of (2E,5E)-2,5-dibenzylidenecyclopentanone and (2E,5E)-bis[(4-dimethylamino)benzylidene]cyclopentanone: Experimental and theoretical study”
- Erratum to “Modified TDAE petroleum plasticiser”
- Corrigendum
- Corrigendum to “A nitric oxide-releasing prodrug promotes apoptosis in human renal carcinoma cells: Involvement of reactive oxygen species”
- Special Issue on 3rd IC3PE 2020
- Visible light-responsive photocatalyst of SnO2/rGO prepared using Pometia pinnata leaf extract
- Antihyperglycemic activity of Centella asiatica (L.) Urb. leaf ethanol extract SNEDDS in zebrafish (Danio rerio)
- Selection of oil extraction process from Chlorella species of microalgae by using multi-criteria decision analysis technique for biodiesel production
- Special Issue on the 14th Joint Conference of Chemistry (14JCC)
- Synthesis and in vitro cytotoxicity evaluation of isatin-pyrrole derivatives against HepG2 cell line
- CO2 gas separation using mixed matrix membranes based on polyethersulfone/MIL-100(Al)
- Effect of synthesis and activation methods on the character of CoMo/ultrastable Y-zeolite catalysts
- Special Issue on Electrochemical Amplified Sensors
- Enhancement of graphene oxide through β-cyclodextrin composite to sensitive analysis of an antidepressant: Sulpiride
- Investigation of the spectroelectrochemical behavior of quercetin isolated from Zanthoxylum bungeanum
- An electrochemical sensor for high sensitive determination of lysozyme based on the aptamer competition approach
- An improved non-enzymatic electrochemical sensor amplified with CuO nanostructures for sensitive determination of uric acid
- Special Issue on Applied Biochemistry and Biotechnology 2020
- Fast discrimination of avocado oil for different extracted methods using headspace-gas chromatography-ion mobility spectroscopy with PCA based on volatile organic compounds
- Effect of alkali bases on the synthesis of ZnO quantum dots
- Quality evaluation of Cabernet Sauvignon wines in different vintages by 1H nuclear magnetic resonance-based metabolomics
- Special Issue on the Joint Science Congress of Materials and Polymers (ISCMP 2019)
- Diatomaceous Earth: Characterization, thermal modification, and application
- Electrochemical determination of atenolol and propranolol using a carbon paste sensor modified with natural ilmenite
- Special Issue on the Conference of Energy, Fuels, Environment 2020
- Assessment of the mercury contamination of landfilled and recovered foundry waste – a case study
- Primary energy consumption in selected EU Countries compared to global trends
- Modified TDAE petroleum plasticiser
- Use of glycerol waste in lactic acid bacteria metabolism for the production of lactic acid: State of the art in Poland
- Topical Issue on Applications of Mathematics in Chemistry
- Theoretical study of energy, inertia and nullity of phenylene and anthracene
- Banhatti, revan and hyper-indices of silicon carbide Si2C3-III[n,m]
- Topical Issue on Agriculture
- Occurrence of mycotoxins in selected agricultural and commercial products available in eastern Poland
- Special Issue on Ethnobotanical, Phytochemical and Biological Investigation of Medicinal Plants
- Acute and repeated dose 60-day oral toxicity assessment of chemically characterized Berberis hispanica Boiss. and Reut in Wistar rats
- Phytochemical profile, in vitro antioxidant, and anti-protein denaturation activities of Curcuma longa L. rhizome and leaves
- Antiplasmodial potential of Eucalyptus obliqua leaf methanolic extract against Plasmodium vivax: An in vitro study
- Prunus padus L. bark as a functional promoting component in functional herbal infusions – cyclooxygenase-2 inhibitory, antioxidant, and antimicrobial effects
- Molecular and docking studies of tetramethoxy hydroxyflavone compound from Artemisia absinthium against carcinogens found in cigarette smoke
- Special Issue on the Joint Science Congress of Materials and Polymers (ISCMP 2020)
- Preparation of cypress (Cupressus sempervirens L.) essential oil loaded poly(lactic acid) nanofibers
- Influence of mica mineral on flame retardancy and mechanical properties of intumescent flame retardant polypropylene composites
- Production and characterization of thermoplastic elastomer foams based on the styrene–ethylene–butylene–styrene (SEBS) rubber and thermoplastic material
- Special Issue on Applied Chemistry in Agriculture and Food Science
- Impact of essential oils on the development of pathogens of the Fusarium genus and germination parameters of selected crops
- Yield, volume, quality, and reduction of biotic stress influenced by titanium application in oilseed rape, winter wheat, and maize cultivations
- Influence of potato variety on polyphenol profile composition and glycoalcaloid contents of potato juice
- Carryover effect of direct-fed microbial supplementation and early weaning on the growth performance and carcass characteristics of growing Najdi lambs
- Special Issue on Applied Biochemistry and Biotechnology (ABB 2021)
- The electrochemical redox mechanism and antioxidant activity of polyphenolic compounds based on inlaid multi-walled carbon nanotubes-modified graphite electrode
- Study of an adsorption method for trace mercury based on Bacillus subtilis
- Special Issue on The 1st Malaysia International Conference on Nanotechnology & Catalysis (MICNC2021)
- Mitigating membrane biofouling in biofuel cell system – A review
- Mechanical properties of polymeric biomaterials: Modified ePTFE using gamma irradiation
Articles in the same Issue
- Regular Articles
- Qualitative and semi-quantitative assessment of anthocyanins in Tibetan hulless barley from different geographical locations by UPLC-QTOF-MS and their antioxidant capacities
- Effect of sodium chloride on the expression of genes involved in the salt tolerance of Bacillus sp. strain “SX4” isolated from salinized greenhouse soil
- GC-MS analysis of mango stem bark extracts (Mangifera indica L.), Haden variety. Possible contribution of volatile compounds to its health effects
- Influence of nanoscale-modified apatite-type calcium phosphates on the biofilm formation by pathogenic microorganisms
- Removal of paracetamol from aqueous solution by containment composites
- Investigating a human pesticide intoxication incident: The importance of robust analytical approaches
- Induction of apoptosis and cell cycle arrest by chloroform fraction of Juniperus phoenicea and chemical constituents analysis
- Recovery of γ-Fe2O3 from copper ore tailings by magnetization roasting and magnetic separation
- Effects of different extraction methods on antioxidant properties of blueberry anthocyanins
- Modeling the removal of methylene blue dye using a graphene oxide/TiO2/SiO2 nanocomposite under sunlight irradiation by intelligent system
- Antimicrobial and antioxidant activities of Cinnamomum cassia essential oil and its application in food preservation
- Full spectrum and genetic algorithm-selected spectrum-based chemometric methods for simultaneous determination of azilsartan medoxomil, chlorthalidone, and azilsartan: Development, validation, and application on commercial dosage form
- Evaluation of the performance of immunoblot and immunodot techniques used to identify autoantibodies in patients with autoimmune diseases
- Computational studies by molecular docking of some antiviral drugs with COVID-19 receptors are an approach to medication for COVID-19
- Synthesis of amides and esters containing furan rings under microwave-assisted conditions
- Simultaneous removal efficiency of H2S and CO2 by high-gravity rotating packed bed: Experiments and simulation
- Design, synthesis, and biological activities of novel thiophene, pyrimidine, pyrazole, pyridine, coumarin and isoxazole: Dydrogesterone derivatives as antitumor agents
- Content and composition analysis of polysaccharides from Blaps rynchopetera and its macrophage phagocytic activity
- A new series of 2,4-thiazolidinediones endowed with potent aldose reductase inhibitory activity
- Assessing encapsulation of curcumin in cocoliposome: In vitro study
- Rare norisodinosterol derivatives from Xenia umbellata: Isolation and anti-proliferative activity
- Comparative study of antioxidant and anticancer activities and HPTLC quantification of rutin in white radish (Raphanus sativus L.) leaves and root extracts grown in Saudi Arabia
- Comparison of adsorption properties of commercial silica and rice husk ash (RHA) silica: A study by NIR spectroscopy
- Sodium borohydride (NaBH4) as a high-capacity material for next-generation sodium-ion capacitors
- Aroma components of tobacco powder from different producing areas based on gas chromatography ion mobility spectrometry
- The effects of salinity on changes in characteristics of soils collected in a saline region of the Mekong Delta, Vietnam
- Synthesis, properties, and activity of MoVTeNbO catalysts modified by zirconia-pillared clays in oxidative dehydrogenation of ethane
- Synthesis and crystal structure of N,N′-bis(4-chlorophenyl)thiourea N,N-dimethylformamide
- Quantitative analysis of volatile compounds of four Chinese traditional liquors by SPME-GC-MS and determination of total phenolic contents and antioxidant activities
- A novel separation method of the valuable components for activated clay production wastewater
- On ve-degree- and ev-degree-based topological properties of crystallographic structure of cuprite Cu2O
- Antihyperglycemic effect and phytochemical investigation of Rubia cordifolia (Indian Madder) leaves extract
- Microsphere molecularly imprinted solid-phase extraction for diazepam analysis using itaconic acid as a monomer in propanol
- A nitric oxide-releasing prodrug promotes apoptosis in human renal carcinoma cells: Involvement of reactive oxygen species
- Machine vision-based driving and feedback scheme for digital microfluidics system
- Study on the application of a steam-foam drive profile modification technology for heavy oil reservoir development
- Ni–Ru-containing mixed oxide-based composites as precursors for ethanol steam reforming catalysts: Effect of the synthesis methods on the structural and catalytic properties
- Preparation of composite soybean straw-based materials by LDHs modifying as a solid sorbent for removal of Pb(ii) from water samples
- Synthesis and spectral characterizations of vanadyl(ii) and chromium(iii) mixed ligand complexes containing metformin drug and glycine amino acid
- In vitro evaluation of lactic acid bacteria with probiotic activity isolated from local pickled leaf mustard from Wuwei in Anhui as substitutes for chemical synthetic additives
- Utilization and simulation of innovative new binuclear Co(ii), Ni(ii), Cu(ii), and Zn(ii) diimine Schiff base complexes in sterilization and coronavirus resistance (Covid-19)
- Phosphorylation of Pit-1 by cyclin-dependent kinase 5 at serine 126 is associated with cell proliferation and poor prognosis in prolactinomas
- Molecularly imprinted membrane for transport of urea, creatinine, and vitamin B12 as a hemodialysis candidate membrane
- Optimization of Murrayafoline A ethanol extraction process from the roots of Glycosmis stenocarpa, and evaluation of its Tumorigenesis inhibition activity on Hep-G2 cells
- Highly sensitive determination of α-lipoic acid in pharmaceuticals on a boron-doped diamond electrode
- Synthesis, chemo-informatics, and anticancer evaluation of fluorophenyl-isoxazole derivatives
- In vitro and in vivo investigation of polypharmacology of propolis extract as anticancer, antibacterial, anti-inflammatory, and chemical properties
- Topological indices of bipolar fuzzy incidence graph
- Preparation of Fe3O4@SiO2–ZnO catalyst and its catalytic synthesis of rosin glycol ester
- Construction of a new luminescent Cd(ii) compound for the detection of Fe3+ and treatment of Hepatitis B
- Investigation of bovine serum albumin aggregation upon exposure to silver(i) and copper(ii) metal ions using Zetasizer
- Discoloration of methylene blue at neutral pH by heterogeneous photo-Fenton-like reactions using crystalline and amorphous iron oxides
- Optimized extraction of polyphenols from leaves of Rosemary (Rosmarinus officinalis L.) grown in Lam Dong province, Vietnam, and evaluation of their antioxidant capacity
- Synthesis of novel thiourea-/urea-benzimidazole derivatives as anticancer agents
- Potency and selectivity indices of Myristica fragrans Houtt. mace chloroform extract against non-clinical and clinical human pathogens
- Simple modifications of nicotinic, isonicotinic, and 2,6-dichloroisonicotinic acids toward new weapons against plant diseases
- Synthesis, optical and structural characterisation of ZnS nanoparticles derived from Zn(ii) dithiocarbamate complexes
- Presence of short and cyclic peptides in Acacia and Ziziphus honeys may potentiate their medicinal values
- The role of vitamin D deficiency and elevated inflammatory biomarkers as risk factors for the progression of diabetic nephropathy in patients with type 2 diabetes mellitus
- Quantitative structure–activity relationship study on prolonged anticonvulsant activity of terpene derivatives in pentylenetetrazole test
- GADD45B induced the enhancing of cell viability and proliferation in radiotherapy and increased the radioresistance of HONE1 cells
- Cannabis sativa L. chemical compositions as potential plasmodium falciparum dihydrofolate reductase-thymidinesynthase enzyme inhibitors: An in silico study for drug development
- Dynamics of λ-cyhalothrin disappearance and expression of selected P450 genes in bees depending on the ambient temperature
- Identification of synthetic cannabinoid methyl 2-{[1-(cyclohexylmethyl)-1H-indol-3-yl] formamido}-3-methylbutanoate using modern mass spectrometry and nuclear magnetic resonance techniques
- Study on the speciation of arsenic in the genuine medicinal material honeysuckle
- Two Cu(ii)-based coordination polymers: Crystal structures and treatment activity on periodontitis
- Conversion of furfuryl alcohol to ethyl levulinate in the presence of mesoporous aluminosilicate catalyst
- Review Articles
- Hsien Wu and his major contributions to the chemical era of immunology
- Overview of the major classes of new psychoactive substances, psychoactive effects, analytical determination and conformational analysis of selected illegal drugs
- An overview of persistent organic pollutants along the coastal environment of Kuwait
- Mechanism underlying sevoflurane-induced protection in cerebral ischemia–reperfusion injury
- COVID-19 and SARS-CoV-2: Everything we know so far – A comprehensive review
- Challenge of diabetes mellitus and researchers’ contributions to its control
- Advances in the design and application of transition metal oxide-based supercapacitors
- Color and composition of beauty products formulated with lemongrass essential oil: Cosmetics formulation with lemongrass essential oil
- The structural chemistry of zinc(ii) and nickel(ii) dithiocarbamate complexes
- Bioprospecting for antituberculosis natural products – A review
- Recent progress in direct urea fuel cell
- Rapid Communications
- A comparative morphological study of titanium dioxide surface layer dental implants
- Changes in the antioxidative properties of honeys during their fermentation
- Erratum
- Erratum to “Corrosion study of copper in aqueous sulfuric acid solution in the presence of (2E,5E)-2,5-dibenzylidenecyclopentanone and (2E,5E)-bis[(4-dimethylamino)benzylidene]cyclopentanone: Experimental and theoretical study”
- Erratum to “Modified TDAE petroleum plasticiser”
- Corrigendum
- Corrigendum to “A nitric oxide-releasing prodrug promotes apoptosis in human renal carcinoma cells: Involvement of reactive oxygen species”
- Special Issue on 3rd IC3PE 2020
- Visible light-responsive photocatalyst of SnO2/rGO prepared using Pometia pinnata leaf extract
- Antihyperglycemic activity of Centella asiatica (L.) Urb. leaf ethanol extract SNEDDS in zebrafish (Danio rerio)
- Selection of oil extraction process from Chlorella species of microalgae by using multi-criteria decision analysis technique for biodiesel production
- Special Issue on the 14th Joint Conference of Chemistry (14JCC)
- Synthesis and in vitro cytotoxicity evaluation of isatin-pyrrole derivatives against HepG2 cell line
- CO2 gas separation using mixed matrix membranes based on polyethersulfone/MIL-100(Al)
- Effect of synthesis and activation methods on the character of CoMo/ultrastable Y-zeolite catalysts
- Special Issue on Electrochemical Amplified Sensors
- Enhancement of graphene oxide through β-cyclodextrin composite to sensitive analysis of an antidepressant: Sulpiride
- Investigation of the spectroelectrochemical behavior of quercetin isolated from Zanthoxylum bungeanum
- An electrochemical sensor for high sensitive determination of lysozyme based on the aptamer competition approach
- An improved non-enzymatic electrochemical sensor amplified with CuO nanostructures for sensitive determination of uric acid
- Special Issue on Applied Biochemistry and Biotechnology 2020
- Fast discrimination of avocado oil for different extracted methods using headspace-gas chromatography-ion mobility spectroscopy with PCA based on volatile organic compounds
- Effect of alkali bases on the synthesis of ZnO quantum dots
- Quality evaluation of Cabernet Sauvignon wines in different vintages by 1H nuclear magnetic resonance-based metabolomics
- Special Issue on the Joint Science Congress of Materials and Polymers (ISCMP 2019)
- Diatomaceous Earth: Characterization, thermal modification, and application
- Electrochemical determination of atenolol and propranolol using a carbon paste sensor modified with natural ilmenite
- Special Issue on the Conference of Energy, Fuels, Environment 2020
- Assessment of the mercury contamination of landfilled and recovered foundry waste – a case study
- Primary energy consumption in selected EU Countries compared to global trends
- Modified TDAE petroleum plasticiser
- Use of glycerol waste in lactic acid bacteria metabolism for the production of lactic acid: State of the art in Poland
- Topical Issue on Applications of Mathematics in Chemistry
- Theoretical study of energy, inertia and nullity of phenylene and anthracene
- Banhatti, revan and hyper-indices of silicon carbide Si2C3-III[n,m]
- Topical Issue on Agriculture
- Occurrence of mycotoxins in selected agricultural and commercial products available in eastern Poland
- Special Issue on Ethnobotanical, Phytochemical and Biological Investigation of Medicinal Plants
- Acute and repeated dose 60-day oral toxicity assessment of chemically characterized Berberis hispanica Boiss. and Reut in Wistar rats
- Phytochemical profile, in vitro antioxidant, and anti-protein denaturation activities of Curcuma longa L. rhizome and leaves
- Antiplasmodial potential of Eucalyptus obliqua leaf methanolic extract against Plasmodium vivax: An in vitro study
- Prunus padus L. bark as a functional promoting component in functional herbal infusions – cyclooxygenase-2 inhibitory, antioxidant, and antimicrobial effects
- Molecular and docking studies of tetramethoxy hydroxyflavone compound from Artemisia absinthium against carcinogens found in cigarette smoke
- Special Issue on the Joint Science Congress of Materials and Polymers (ISCMP 2020)
- Preparation of cypress (Cupressus sempervirens L.) essential oil loaded poly(lactic acid) nanofibers
- Influence of mica mineral on flame retardancy and mechanical properties of intumescent flame retardant polypropylene composites
- Production and characterization of thermoplastic elastomer foams based on the styrene–ethylene–butylene–styrene (SEBS) rubber and thermoplastic material
- Special Issue on Applied Chemistry in Agriculture and Food Science
- Impact of essential oils on the development of pathogens of the Fusarium genus and germination parameters of selected crops
- Yield, volume, quality, and reduction of biotic stress influenced by titanium application in oilseed rape, winter wheat, and maize cultivations
- Influence of potato variety on polyphenol profile composition and glycoalcaloid contents of potato juice
- Carryover effect of direct-fed microbial supplementation and early weaning on the growth performance and carcass characteristics of growing Najdi lambs
- Special Issue on Applied Biochemistry and Biotechnology (ABB 2021)
- The electrochemical redox mechanism and antioxidant activity of polyphenolic compounds based on inlaid multi-walled carbon nanotubes-modified graphite electrode
- Study of an adsorption method for trace mercury based on Bacillus subtilis
- Special Issue on The 1st Malaysia International Conference on Nanotechnology & Catalysis (MICNC2021)
- Mitigating membrane biofouling in biofuel cell system – A review
- Mechanical properties of polymeric biomaterials: Modified ePTFE using gamma irradiation